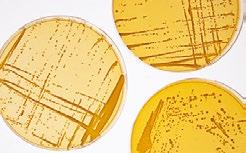

Fachzeitschrift für Brauereien, Mälzereien, Getränkeindustrie und deren Partner Ausgabe 10 | 10. Oktober 2022 | 37. Jahrgang | ISSN 0179-2466 FORUM BRAUEREI Informationsservice der Versuchs- und Lehranstalt für Brauerei in Berlin www.brauerei-forum.de VLB Berlin fusioniert Forschungsinstitute Bericht vom VLB-Symposium "Sauer fermentierte alkoholfreie Getränke", Teil 2 Brau-Börsen-Bilanz: Oetker seit Konzernverkleinerung im Übergang Certified Brewmaster Course 2022 zu Ende IN DIESER AUSGABE: IfGB AKTUELL – Informationen für Brennereien und Spirituosen-Hersteller www.tensid-chemie.com ANLAGENBAU Maßgeschneiderte Lösungen TENSID CHE M IE HYGIENE CONCEPTS TECHNOLOGY • Beratung Kundenorientierte Beratung, Erstellen von Einlagerungsund Versorgungskonzepten • Planung Erstellung von Fließschemata, Prozessbeschreibungen und Auslegung von Aggregaten • Ausführung Koordination, Installation und Inbetriebnahme xx_TC-0957-003_TC_TitelAZ_Brauereiforum_V3.qxp_Layout 1 23.02.20 11:23 Seite 1






Dry-Hopping mit SPECTRUM bedeutet eine erhebliche Steigerung der Ausbeute bei Verringerung der Kontaktzeit im Tank während das volle Aroma des Hopfens im Bier erhalten bleibt. barthhaas.com/de/spectrum ...JETZT MIT SPECTRUM! VLB Berlin, Seestraße 13, 13353 Berlin brewmaster@vlb-berlin.org PRAXISKURS MIKROBIOLOGIE 1-wöchiger Kurs zu mikrobiologischen Anwendungen und Techniken in der Brau- und Getränkeindustrie Themen Mikroorganismen + Mikrobiologische Qualitätskontrolle + Nährmedien + Mikrobiologische Probenahme, Laborarbeit und Analytik www.vlb-berlin.org/praxiskursmibi 28.11.2022 bis 2.12.2022, Präsenzkurs in Berlin Kurssprache: Deutsch
MENSCHEN & UNTERNEHMEN
4 Hanuman Beverages aus Kambodscha ist neues VLB-Mitglied
5 Warsteiner Gruppe: Jens Hoffmann übernimmt von Ulrich Brendel / Franken Brunnen: Dr. Marco Potreck neuer Geschäftsführer Technik
6 Radeberger Gruppe: Binding-Brauerei in Frankfurt wird als Produktionsstandort geschlossen
7 Bitburger Braugruppe: Markus Spanier folgt auf Stephan Fahrig / Krombacher Brauerei: Mit 14 jungen Menschen ins neue Ausbildungsjahr
8 Trauer: Peter Kollnberger im Alter von 92 Jahren verstorben / Dr. Dieter Soltmann mit 87 Jahren verstorben
9 Erlebniswelten: Malzmühle eröffnet die neue „Brauwelt Köln“ / DLG-Qualitätsprüfung Bier und Biermischgetränke 2023 – jetzt anmelden!

TECHNIK & TECHNOLOGIE
10 Fachmessen: drinktec 2022 – trotz weniger Fachbesucher zufriedene Aussteller
12 Nachhaltigkeit: Carlsberg präsentiert neueste Fibre Bottle

13 Deutscher Brauer-Bund: Internet-Plattform soll Versorgung mit Kohlensäure erleichtern
14 Zeppelin Systems: Malzherstellung in Brasilien: Neue Großanlage liefert bis zu 800 Tonnen am Tag
16 Brauer-Schule – Fachfragen und Fachrechnen für Auszubildende: Hefemanagement
17 Envases: 50 Jahre Partyfass – das Minikeg hat Geburtstag
IfGB AKTUELL
18 BSI: Spirituosenkonsum im internationalen Vergleich / Fachliteratur: Daten aus der Alkoholwirtschaft 2022 19 20. IfGB-Forum: „Krisen bedeuten für uns Herausforderung und Umdenken“ 20 GGBW-Vorstand zu Besuch auf der Mitgliederversammlung der Gesellschaft für die Geschichte des Brauwesens in Stralsund / Fachliteratur: Die Geschichte der Haselünner Kornbrennereien
21 Obstbrennertag in Berlin: Brenner und Politiker im Dialog
BETRIEBSWIRTSCHAFT 22 Brau-Börsen-Bilanz: Was bringt das 2. Halbjahr 2022?
MARKT
& MARKEN
26 BestBrewChallenge 2022: Die Sieger kommen aus Bulgarien, Deutschland und Italien 27 E-Commerce: ABInBev startet digitalen B2B-Marktplatz „BEES“ in Deutschland 28 Nachrichten: Becker's zeigt sich verjüngt / European Beer Star 2022: 219 Biere ausgezeichnet

Wulle macht Werbung mit Wulle
SONSTIGES
Hajenski führt seit 35 Jahren die Brauring Kooperation / Craft Brewing in Practice – Gruppenfoto / Lösungen Brauer-Schule / Impressum
Hanuman Beverages, ein junges und aufstrebendes Getränkeunternehmen aus Kambodscha, ist seit Anfang dieses Jahres Mitglied der VLB Berlin
1002 Aussteller trafen auf der drinktec 2022 in München auf rund 50 000 Fachbesucher – aus Sicht der VLB: ein hervorragender Messe-Neustart nach zwei Jahren Zwangspause

Carlsbergs Fibre Bottle, die weltweit erste Bierflasche aus nachhaltig erzeugten Holzfasern und PEF (Polyethylenfuranoat), geht in eine großangelegte Pilotphase über
Das 20. IfGB-Forum zog Ende September rund 100 Spirituosenexperten ins Münsterland. Spannende Vorträge und zwei Betriebsbesichtigungen boten viel Raum für Diskussionen
Brauerei Forum – Oktober 2022
3
INHALT INHALT
10 4 12
29 Dinkelacker:
INSTITUTIONEN & VERBÄNDE 30 DBMB-Landesgruppe Berlin-Brandenburg: Bericht von der Jahreshauptversammlung
31 Matthias
32 Veranstaltungskalender
19
Übergabe der VLB-Mitgliedsurkunde in Phnom Penh im Mai 2022 (v.l.n.r.): Bernd Kirsch (HanumanBraumeister), ein Mitarbeiter der Brauerei, Roberto Biurrun, Mick Holewa, Jan Fischer (alle VLB), Brauereimanager Vatanak, stellvertretender Brauereimanager Visal Ty, Philipp Zeuschner (VLB) und Rolf Sanktjohanser (Betriebsleiter)

Hanuman Beverages aus Kambodscha ist neues VLB-Mitglied
Hanuman Beverages Co Ltd, ein junges und aufstrebendes Getränkeunternehmen aus Kambodscha, ist seit Januar dieses Jahres neues Mitglied der Versuchs- und Lehranstalt für Brauerei in Berlin (VLB).

(oh) Hanuman Beverages hat seinen Sitz in der kambodschanischen Hauptstadt Phnom Penh. Mit einer Gesamtinvestition von 160 Mio. US-Dollar begann das Familienunternehmen 2018 mit dem Bau einer neuen Brauerei am Stadtrand von Phnom Penh. Die erste Ausbaustufe mit einer Kapazität von 1 Mio. hl wurde im Oktober 2021 in Betrieb genommen. Eine zweite Ausbaustufe für bis zu 2 Mio. hl Bier ist bereits in Planung. Gemäß dem Anspruch „Greatness in Every Drop“ legte man großen Wert auf modernste Brau- und Abfülltechnik aus Deutschland für eine nachhaltige und umweltschonende Produktion. Mit mehr als 1000 neuen Arbeitsplätzen will Hanuman auch einen Beitrag zum weiteren wirtschaftlichen Wachstum in Kambodscha leisten.
Sarsileap Khieu, Inhaberin und Vorstandsvorsitzende von Ha -
numan Beverages, und CEO Chas Geschke verfolgen ehrgeizige Pläne: „Kambodscha ist ein Land mit einer sehr jungen Bevölkerung, die sich rasant entwickelt. Unser Ziel ist es, die Marke Hanuman als Benchmark für höchste Qualität auf dem kambodschanischen Getränkemarkt zu etablieren.“ Dabei will das Unternehmen den steigenden Ansprüchen der Kunden mit hochwertigen, innovativen und umweltfreundlichen Produkten gerecht werden: Mit modernster Anlagentechnik, besten Rohstoffen, Wasserrecycling raten von 90 % und dem weitgehenden Verzicht auf Plastikverpackungen will Hanuman die erste klimapositive Brauerei Kambodschas werden.
Erfolgreiche Etablierung am Markt
Eine Goldmedaille bei der Monde Selection Beer im Juni 2022 für
das Flaggschiff „Hanuman Premium Lager“ war eine erste Bestätigung für den erfolgreichen Start des Betriebs. Eine weitere Marke war Hanuman Black, basierend auf der deutschen Biersorte Schwarzbier, die der kambodschanische Markt sehr gut angenommen hat. Darüber hinaus ist eine weitere Produktionsanlage für alkoholfreie Erfrischungsgetränke und Energy Drinks in Planung.
„Bei Hanuman herrscht eine enthusiastische Aufbruchstimmung, die von der Eigentümerfamilie stark unterstützt wird. Die großen Markterfolge unmittelbar nach dem Produktionsstart bestätigen, dass wir auf dem richtigen Weg sind“, fasst der deutsche Braumeister und Diplom-Biersommelier Bernd Kirsch seine Erfahrungen der vergangenen zwei Jahre bei Hanuman zusammen. „Wir sind froh, mit der VLB Berlin einen kompetenten und unabhängigen Partner an unserer Seite zu haben, der uns beim weiteren Ausbau unserer Bier- und Getränkeaktivitäten unterstützen wird.“
Auch die VLB freut sich über die neue Kooperation: „Es ist eine besondere Ehre für uns, mit Hanuman Beverages ein weiteres Mitglied aus Südostasien in unserer VLB-Familie begrüßen zu dürfen“, sagt VLB-Geschäftsführer Dr. Josef Fontaine. „Das Unternehmen hat einen sehr ehrgeizigen und äußerst professionellen Ansatz. Wir sind stolz darauf, Hanuman in seiner weiteren Entwicklung unterstützen zu können, und freuen uns auf eine fruchtbare Zusammenarbeit!“
4 Brauerei Forum – Oktober 2022 MENSCHEN & UNTERNEHMEN VLB AKTUELL
www.hanumanbeverages.com
Foto: Hanuman Beverages
Warsteiner Gruppe
Jens Hoffmann übernimmt von Ulrich Brendel
Jens Hoffmann, seit längerer Zeit dem Familienunternehmen als Berater verbunden, stößt nun zur Geschäftsführung der Warsteiner Gruppe. In seiner neuen Rolle als Geschäftsführer Technik und Logistik trägt er ab dem 1. November die Gesamtverantwortung für die sieben Brauereistandorte sowie für die strategische und internationale Weiterentwicklung der Unternehmens-Gruppe.
(F.) Ulrich Brendel wird nach 30 erfolgreichen Jahren in der Warsteiner Gruppe das Unternehmen zum Jahreswechsel auf eigenen Wunsch verlassen. Er möchte noch einmal ein neues Kapitel in seiner beruflichen Laufbahn aufschlagen. Jens Hoffmann, gelernter Braumeister und Betriebswirt, kann auf Erfahrung in führenden Managementpositionen der Getränkebranche verweisen und verfügt über internationale Expertise. Zuletzt agierte er als Technischer Leiter und strategischer Berater der Ratsherrn Brauerei in Hamburg. Eine der maßgeblichen Stationen seiner Karriere war die Anheuser-Busch InBev Ger-
many Holding GmbH, bei der er vor seinem Wechsel nach Hamburg als Director für die innerdeutsche und internationale Supply Chain sowie als Geschäftsführer agierte. Catharina Cramer, Inhaberin der Warsteiner Gruppe, betont: „Dass wir so ein Branchenschwergewicht wie Jens Hoffmann für uns gewinnen konnten, macht mich stolz. Durch verschiedene gemeinsame Projekte in den vergangenen zwei Jahren weiß ich, wie gut Jens zu unserem Familienunternehmen passt.“
Ulrich Brendel war maßgeblich für die Weiterentwicklung der gruppenweiten Braustätten in den Bereichen Technik und Strategie zuständig. Als Geschäftsführer Technik verantwortete er zuletzt den operativen Betrieb aller Braustätten sowie das Supply-Chain-Management. Seinen Einstieg in die Brauereigruppe fand Brendel 1992 nach seiner Ausbildung zum Energieanlagenelektroniker und dem Studium der Elektrotechnik. Catharina Cramer verabschiedet sich schweren Herzens von ihrem langjährigen Mitarbeiter und vertrauten Berater: „Knapp 30 Jahre lang war Uli ein Mitarbeiter,
auf den man sich immer verlassen konnte. Für mich persönlich gehört er mit all seinen Verdiensten für die Gruppe stets zur Warsteiner Familie. Ich finde es sehr schade, dass er uns verlässt, und freue mich gleichzeitig, dass für ihn ein neues Kapitel beginnt.“
Mit dem Einstieg Hoffmanns setzt sich die operative Warsteiner-Geschäftsführung ab dem 1. November wie folgt zusammen: Helmut Hörz (CEO und CFO), Uwe Albershardt (Geschäftsführer Vertrieb und Marketing) und Jens Hoffmann (Geschäftsführer Technik und Logistik).

Jens Hoffmann (oben) übernimmt ab 1. November die Nachfolge von Ulrich Brendel (unten) als Geschäftsführer Technik und Logistik bei der Warsteiner
Dr. Marco Potreck neuer Geschäftsführer Technik
Mit Wirkung zum 1. Oktober 2022 hat Dr. Marco Potreck als Geschäftsführer Qualität, Umwelt, Technik der Franken Brunnen GmbH & Co. KG seinen Aufgabenbereich erweitert.
(F.) Dr. Marco Potreck (53), seit 1. November 2019 als Betriebsleiter und Prokurist am Standort Eilenburg tätig, hat zum 1. Oktober neben seiner bisherigen Tätigkeit zusätzlich die Verantwortung für die technischen Bereiche der vier Franken-Brunnen-Standorte Neustadt/Aisch, Bad Windsheim, Bad


Kissingen und Eilenburg übernommen. Für die Tochtergesellschaften Romina, Sinzig und Oberselters wird er zudem Koordinierungsaufgaben bei technischen Fragen wahrnehmen. Er berichtet weiterhin direkt an den Vorsitzenden der Zentralgeschäftsführung, Michael Bartholl.
Mit der Berufung in die Geschäftsführung ist ein weiterer Baustein des neuen Unternehmensmodells mit operativ verantwortlichen Regionalgeschäftsführern und einer übergreifenden Zentralgeschäftsführung umgesetzt.
5 Brauerei Forum – Oktober 2022
Fotos: Warsteiner
Brauereigruppe
Franken Brunnen
Foto: Franken Brunnen
Radeberger Gruppe
Binding-Brauerei in Frankfurt wird als Produktionsstandort geschlossen
Die Radeberger Gruppe passt ihre Aufstellung an langfristige Marktentwicklungen an und nimmt ihren Frankfurter Produktions- und Abfüllstandort bis Oktober 2023 schrittweise vom Markt. Die Marken sollen erhalten bleiben, die Produktion wird gruppenintern verlagert. Die Zentrale der Radeberger Gruppe in Frankfurt ist von dieser Maßnahme ausdrücklich nicht betroffen, sie wird weiterhin ihren Sitz am Sachsenhäuser Berg haben.
Die Frankfurter Zentrale der größten deutschen Brauereigruppe
Foto: Radeberger
(F.) Die Radeberger Gruppe wird den Produktions- und Abfüllbetrieb an ihrem Frankfurter Standort, der Binding-Brauerei, bis spätestens Oktober 2023 einstellen sowie die dort produzierten und abgefüllten Marken und Mengen schrittweise auf Schwesterstandorte verlagern. Dies gab die größte deutsche Brauereigruppe Ende September bekannt. Man stelle sich auf einen, durch strukturelle Veränderungen
sonderen Standort zu erhalten: So haben wir sämtliche alternative Ansätze und Routen ausgelotet, Spielräume genutzt und damit über Jahre auch wirtschaftliche Nachteile in Kauf genommen mit dem Ziel, diese schwere Entscheidung nicht treffen zu müssen. Vor dem Hintergrund der jüngsten Krisen, der massiven Belas tungen, mit denen sich die deutschen Brauer konfrontiert sehen, und nicht zuletzt der dramatischen Kostenexplosionen, die wir als Branche schultern müssen, ist das für die Unternehmensgruppe nun leider nicht mehr länger darstellbar“, beschreibt Guido Mockel, Sprecher der Geschäftsführung der Radeberger Gruppe, die Hintergründe.
vermeiden. Doch auch im Sinne unserer verbleibenden rund 6800 Mitarbeitenden müssen wir diesen Schritt nun konsequent gehen, so schwer uns das auch fällt“, betont Guido Mockel. „Somit dient diese Maßnahme an einem Standort der nachhaltigen Stärkung anderer Standorte.“
langfristig weiter rückläufigen, vor allem aber durch die langen Schatten der Krisen zusätzlich empfindlich unter Druck stehenden Biermarkt ein. Darüber hinaus nehme Radeberger aktiv wirtschaftlich stark belastende Überkapazitäten aus dem Markt und sorgt für eine optimierte Auslastung und Stärkung ihrer Braustandorte in allen Regionen Deutschlands.
Dauerkrisen unternehmerisch nicht mehr abfederbar „Wir haben lange gerungen, die Frankfurter Binding-Brauerei als einen für uns alle emotional be -
Die Branche habe sich noch nicht annähernd von den Folgen der Pandemie erholt und ächze nun bereits unter den wohl dramatischsten Kostensteigerungen seit Ende des Zweiten Weltkriegs. „Allein in unserer Unternehmensgruppe belaufen sich diese Belastungen nach derzeitigem Stand bereits auf einen zusätzlichen dreistelligen Millionenbetrag, Tendenz weiter steigend. Eine Summe, die sich nicht mehr allein durch Effizienzsteigerungen abfedern lässt“, so der Brauereichef.
Sozialverträgliche Lösungen Über die Entscheidung und weitere Planung hat die Unternehmensgruppe ihre Belegschaften bereits informiert: „Wir wissen, dass wir damit unsere Kolleginnen und Kollegen der Binding-Brauerei hart treffen. Deswegen haben wir in den Vorjahren viele Schleifen gedreht und Maßnahmen umgesetzt, um diese Standortschließung zu
Die von der Binding-Brauerei gebrauten und abgefüllten Marken und Mengen bleiben über das Ende des Frankfurter Produktionsstandortes hinaus nach bewährten Rezepturen erhalten. Für die betroffenen rund 150 Mitarbeitenden wird die Radeberger Gruppe in den jetzt anlaufenden Gesprächen mit den Arbeitnehmervertretungen, wo immer möglich, sozialverträgliche Lösungen suchen. Das können zum Beispiel Angebote für Altersteilzeit oder auch alternative Jobangebote an anderen Standorten sein.
Unternehmenszentrale bleibt in Frankfurt
Die größte private deutsche Brauereigruppe mit ihren deutschlandweit weiterhin 13 Braustandorten und ihrem Mineralbrunnen in Löhnberg wird auch weiterhin von der Mainmetropole aus geführt. Rund 380 Mitarbeitende sorgen in der Frankfurter Hauptverwaltung auch künftig für eine zentrale Steuerung der zahlreichen nationalen wie regionalen Engagements der Unternehmensgruppe im Bier- und Getränkemarkt, die mehr als 80 Marken in ihrem breit gefächerten Portfolio führt, größter Fassbiervermarkter Deutschlands ist und ihre Branche auch als führender Getränkelogistiker sowie Betreiber von Getränkefachmärkten kraftvoll gestalten will.

6 Brauerei Forum – Oktober 2022 MENSCHEN & UNTERNEHMEN
Bitburger Braugruppe
Markus Spanier folgt auf Stephan Fahrig
Markus Spanier (55), bisheriger Leiter Controlling/Beteiligungsmanagement bei der Bitburger Braugruppe, wird ab 1. Januar 2023 die Nachfolge von Stephan Fahrig als Geschäftsführer Finanzen, IT und Einkauf antreten. Fahrig wird das Unternehmen verlassen und sich neuen Aufgaben widmen.

(F.) Um einen nahtlosen Wechsel an der Spitze des Unternehmens sicherzustellen, verantwortet Markus Spanier bereits seit 1. Oktober den kaufmännischen Bereich und leitet die Braugruppe zusammen mit den Geschäftsführern Jan Niewodniczanski (Technik und Umwelt und Vertreter der Unternehmerfamilie), Dr. Stefan Schmitz (Personal und Recht) und Stephan Fahrig (Finanzen, IT und Einkauf).
„Wir danken Stephan Fahrig schon jetzt für seinen großen Einsatz, sein unermüdliches Engagement und für das, was er in den vergangenen sechs Jahren für die Braugruppe erreicht hat“, sagt Dr. Dieter Heuskel, Vorsitzender der Aufsichtsgremien der Bitburger Unternehmensgruppe. Er habe die Digitalisierung entscheidend mit vorangetrieben und die wirtschaftlichen Herausforderungen infolge externer Krisen, wie bspw. Corona-Pandemie und Flut im Ahrtal, gemeistert. „Wir wünschen ihm für die Zukunft alles Gute“, so Heuskel weiter.
Markus Spanier ist bereits seit 2005 in verschiedenen leitenden Positionen bei der Bitburger Unternehmensgruppe tätig, zuletzt verantwortete er das Ressort Controlling/ Beteiligungsmanagement. Spanier,
der mit seiner Familie in der Region beheimatet ist, ist seit 2015 auch Geschäftsführer der Bitburger Kontor-Gruppe.
„Wir freuen uns sehr, mit Markus Spanier einen erfahrenen, hochqualifizierten Fachmann mit tiefgehenden Branchenkenntnissen in der Geschäftsführung begrüßen zu können“, äußert sich Heuskel über den Wechsel an der Spitze.
Foto: Bitburger Markus Spanier folgt auf Stephan Fahrig als Geschäftsführer Finanzen, IT und Einkauf
Mit 14 jungen Menschen ins neue Ausbildungsjahr
Zwölf Auszubildende und dual Studierende konnte die Krombacher Brauerei zum diesjährigen Ausbildungsstart begrüßen – drei von ihnen am Standort in Steinfurt. Zwei Auszubildende setzen nach ihrem erfolgreichen Abschluss ihren Berufsweg bei Krombacher mit einem dualen Studium fort.
(F.) Um den Einstieg zu erleichtern, lernen die Neuzugänge in der traditionellen Einführungswoche die Geschäftsführung und Ausbilder der einzelnen Abteilungen kennen. Gemeinsam werden sie die jungen Kollegen in ihrer Ausbildung unterstützen und bei ihrer Entwicklung bestmöglich fördern. „Der Berufseinstieg ist etwas ganz Besonderes und bei manchen ist die Aufregung groß. Uns ist es daher besonders wichtig, unsere offene Unternehmenskultur schon beim Ausbildungsstart zu vermitteln“, erklärt Milena Jannek, Ausbildungs-
leiterin der Krombacher Brauerei. Die Ausbildung bei Krombacher geht über die reine Vermittlung von fachspezifischen Inhalten hinaus: Neben einer Azubi-Akademie am Biggesee gehört auch die interne Krombacher Nachhaltigkeits-Akademie mit zum Ausbildungsplan.
„Ausbildung heißt für uns mehr, als Berufseinsteiger für den Joballtag fit zu machen. Wir möchten insgesamt einen Blick über den Tellerrand ermöglichen. Mit der Nachhaltigkeits-Akademie geben wir unserem Nachwuchs die Möglichkeit, das Nachhaltigkeitsengagement der Brauerei aktiv mitzugestalten“, so Jannek weiter.
Jedes Jahr bietet die Krombacher Brauerei in verschiedenen Berufsfeldern Ausbildungen an: Dazu gehören handwerkliche und gewerbliche sowie kaufmännische Berufe. Auch für den Ausbildungsjahrgang 2023 sucht die Krombacher Brauerei bereits nach motivierten und
engagierten Auszubildenden und dual Studierenden, die ihren beruflichen Weg mit dem inhabergeführten Familienunternehmen gehen möchten.
Interessierte können sich unter www.krombacher.de/ausbildung informieren und bewerben.
Für sie beginnt ein neuer Lebensabschnitt: Insgesamt 14 junge Menschen haben bei der Krombacher Brauerei ihre Ausbildung begonnen

7 Brauerei Forum – Oktober 2022
Krombacher Brauerei
Foto: Krombacher
Mit diesem Foto kündigte die Tageszeitung für Brauerei am 25. Juni 1985 den Eintritt Peter Kollnbergers in den Dienst der VLB Berlin an
Peter Kollnberger im Alter von 92 Jahren verstorben
Die VLB Berlin trauert um den ehemaligen Leiter der Maschinentechnischen Abteilung Peter Kollnberger, der am 9. August 2022 im Alter von 92 Jahren verstorben ist.
(BF) „Die VLB freut sich, eine solch erfahrene Persönlichkeit für das umfangreiche Aufgabengebiet des Leiters ihrer Maschinentechnischen Abteilung gewonnen zu haben“, war am 25. Juni 1985 in der Tageszeitung für Brauerei zu lesen. Und in der Tat war der Erfahrungsschatz, den Kollnberger aufgrund seines profunden technischen Wissens auf dem Brauereisektor und zahlreicher Auslandstätigkeiten mitbrachte, von unschätzbarem Wert für die VLB Berlin und den TechnischWissenschaftlichen Ausschuss. Doch auch im Rahmen seiner Tätigkeit an der Brauerlehranstalt
der VLB und als Lehrbeauftragter der TU Berlin gab er sein Wissen an den Nachwuchs weiter. Peter Kollnberger wurde am 3. Juli 1930 als Sohn österreichischer Eltern in Linz geboren. Nach der mittleren Reife absolvierte der junge Kollnberger eine Lehre als Starkstrommonteur bei der AEG in Stuttgart. Im Anschluss studierte er an der Staatlichen Ingenieurschule in Esslingen und ließ sich später zum Schweißfachingenieur ausbilden. Auf dieses grundsolide Fundament folgte eine jahrzehntelange praktische Tätigkeit im Brauereimaschinensektor. Von 1955 bis 1967 war er bei der Firma A. Ziemann GmbH für die Fabrikation von Brauereianlagen eingesetzt. Von 1971 bis 1979 verantwortete er, abermals bei Ziemann, als Technischer Leiter die Sparte Konstruktion, später den Gesamtbereich Brauerei. In den Zwischenjahren wirkte er als Mon -
tageingenieur in Manila. Bei der San Miguel Brewery war er für die Planung, Konstruktion und Inbetriebnahme einer Sudhauserweiterung zuständig. Von 1979 bis 1981 ging er erneut auf die Philippinen und arbeitete als Projektmanager für die Asia Brewery Manila. Zurück in Deutschland übernahm Peter Kollnberger 1982 die Position als Technischer Geschäftsführer bei der Firma A. Steinecker GmbH. Am 1. Juli 1985 trat er in den Dienst der VLB, deren persönliches Mitglied er nach seiner aktiven Zeit bis zum Schluss blieb.
Ein Leben ganz im Zeichen der Ingenieurskunst ist Anfang August zu Ende gegangen. Am 23. Juli 1990 war im Brauerei Forum zu lesen: „Das Wesen Peter Kollnbergers lässt sich mit engagierter Hilfsbereitschaft kennzeichnen. Und so ist er ‚ein guter Geist‘ der VLB geworden.“ Ruhe er in Frieden.
Dr. Dieter Soltmann mit 87 Jahren verstorben
Der Brauerbund trauert um den früheren Präsidenten und VizePräsidenten Dr. Dieter Soltmann, der am 26. Juli im Alter von 87 Jahren verstorben ist.

(F.) „Dr. Dieter Soltmann hat die deutsche Brauwirtschaft geprägt wie kaum eine andere Unternehmerpersönlichkeit. Mit tiefer Betroffenheit haben wir die Nachricht von seinem Tod aufgenommen. Dieter Soltmann lenkte mit großer Leidenschaft und hohem persönlichen Einsatz nicht nur erfolgreich die Geschicke seines Unternehmens, sondern förderte in ehrenamtlicher Arbeit auch zahlreiche Institutionen, die noch lange
von seinem Lebenswerk profitieren werden“, betonen die Präsidenten des Deutschen Brauer-Bundes und des Bayerischen Brauerbundes, Dr. Jörg Lehmann und Georg Schneider. Der am 17. März 1935 geborene Soltmann absolvierte ein Studium an der Technischen Universität München-Weihenstephan, das er als DiplomIngenieur und DiplomBraumeister abschloss. Dort folgte anschließend auch seine Promotion bei Prof. Ludwig Narziß. 1971 trat Soltmann in die Gabriel Sedlmayr Spaten-Franziskaner-Bräu KGaA ein und arbeitete zunächst in der Marketing-Abteilung. 1976 wurde er persönlich haftender, geschäftsführender Gesellschafter – eine Funktion, die er bis zum Jahr 2000 innehatte.
Soltmann war von 1984 bis 1987 Vize-Präsident des Deutschen Brauer-Bundes und von 1987 bis 1990 Präsident. In seine Amtszeit fiel die juristische, aber auch politische und mediale Auseinandersetzung um die Verbindlichkeit des Reinheitsgebots in Deutschland auch für Bier aus anderen EU-Ländern, die mit dem Urteil des Europäischen Gerichtshofs vom März 1987 endete. In Würdigung seiner großen Verdienste um die deutsche Brauwirtschaft und ihren Spitzenverband ernannte der Deutsche Brauer-Bund Dieter Soltmann im Sommer 1990 zum Ehrenmitglied. 1992 wurde er in das Präsidium des Bayerischen Brauerbundes und zu dessen Schatzmeister gewählt, ein Ehrenamt, das er bis 1998 bekleidete. Noch im selben Jahr ernannte ihn der Bayerische Brauerbund zum Ehrenpräsidenten.

8 Brauerei Forum – Oktober 2022
TRAUER
MENSCHEN & UNTERNEHMEN
Malzmühle eröffnet die neue „Brauwelt Köln“
Am 1. September 2022 eröffnete die „Brauwelt Köln“ auf dem historischen Gelände der Sünner Brauerei in Köln-Kalk. Ganz nach dem Vorbild anderer berühmter Bierstädte wie Dublin, München oder Prag wird mit der neuen Brauwelt auch für die Rheinmetropole eine Erlebnis- und Genusswelt mit vielen Attraktionen rund um die Themen „Bier brauen“ und „Spirituosen brennen“ geschaffen.

(F.) Die Gäste der Brauwelt Köln erwarten unterschiedlichste Brauereiführungen, Erlebnistouren, Bier- und Gin-Tastings, spezielle Angebote für Firmen- und Privatfeiern sowie zahlreiche Workshops und Seminare rund um das Thema Bierbrauen und die Herstellung von Spirituosen. So kann man etwa in der Brauwelt-Akademie das „Kleiner-Braumeister-Diplom“ erwerben sowie sein eigenes Bier brauen und seinen eigenen Gin herstellen. In den ehemaligen Eiskellern befindet sich das 1000 m² große Brauhaus mit Räumlichkeiten für Veranstaltungen und Events in allen Größenordnungen von bis zu 400 Personen. Auf dem Außengelände lockt der Biergarten zu Kölscher Küche und kulturellen Veranstaltungen. Hier kann sich jeder Gast z.B. auch ein individuelles TastingSet aus den unterschiedlichen Spirituosen bzw. Gin-Sorten zusammenstellen lassen. Die kleinen Gäste können die Premiumlimonaden „Kölsches Wasser“ in fünf Geschmacksvarianten als Getränk oder als Slash-Eis genießen.
Denkmalgeschützt
Der ehemalige Technikraum im traditionellen Industriecharme wurde zum neuen Tasting- und Verkaufsraum umgestaltet. Der Brauwelt-Showroom lädt darüber hinaus nicht nur zum Erwerb oder zum Probieren der verschiedenen Biere und Spirituosen ein, sondern beeindruckt auch mit Kölns ältester Dampfmaschine.

In dem historischen Raum zwischen Brennerei und Sudhaus können die hochwertigen Spirituosen auch gleich selbst abgefüllt und personalisiert werden. „Ganz nach dem
Vorbild anderer berühmter Bierstädte wollten wir auch für Köln eine Erlebnis- und Genusswelt für alle Freunde der Kölschen Brau- und Brennkunst schaffen“, erklärt Geschäftsführer Dr. Michael Rosenbaum und fügt hinzu: „Wir geben unseren Gästen hier die Möglichkeit, sich durch unser breites Portfolio an 11 verschiedenen Bieren und 14 verschiedenen Spirituosen zu probieren, die allesamt hier in Köln-Kalk produziert werden.“
Die beiden ältesten familiengeführten Brauereien Kölns, die ihre Bierspezialitäten noch traditionell von Hand brauen, haben sich Anfang 2022 zusammengetan. Unter dem neuen Namen Brauwelt Köln vereinen sich mit der Sünner Brauerei (1830) und der Brauerei zur Malzmühle (1858) zwei wahre Kölner Traditions-Unternehmen unter einem Dach auf dem geschichtsträchtigen und denkmalgeschützten Gelände in Köln-Kalk.
Deutsche Landwirtschafts-Gesellschaft (DLG) DLG-Qualitätsprüfung Bier und Biermischgetränke 2023 – jetzt anmelden!
(F.) Umfangreiche, strenge Prüfkriterien, Laboranalysen und eine Experten-Jury, die sich aus sensorisch geschulten Prüfern zusammensetzt, machen die DLG-Qualitätsprüfung zu den wissenschaftlich anspruchsvollsten und objektivsten Qualitätsprüfungen ihrer Branche. Die DLG-Auszeichnungen stehen für Qualität, Sicherheit und Verlässlichkeit, sie genießen Bekanntheit und Vertrauen. Herausfordernde Zeiten erfordern Flexibilität und Kreativität in der Vermarktung. „Mit ausgezeichneter Bier-Qualität punkten Sie immer. Nutzen Sie deshalb die aussagekräftigen (Sonder-)Auszeichnungen der
DLG für Ihr überzeugendes Qualitätsbekenntnis – die Aufmerksamkeit Ihrer Kunden ist Ihnen sicher“, sagt Thomas Burkhardt, Projektleiter Bier am DLG-Testzentrum Lebensmittel. Burkhardt fordert interessierte Brauer dazu auf, ihre Biere und Biermischgetränke anzumelden und an der DLGQualitätsprüfung 2023 teilzunehmen. Anmeldeschluss ist der
21. Oktober 2022
Weiterführende Informationen gibt es auf der Webseite unter www.dlg.org.

9 Brauerei Forum – Oktober 2022
ERLEBNISWELTEN
Fotos: Brauwelt Köln
Sudhaus der Brauerei (l.); Showroom der Brauwelt Köln mit Dampfmaschine (r.)
drinktec 2022 – trotz weniger Fachbesucher zufriedene Aussteller
1002 Aussteller aus 55 Ländern trafen auf der drinktec 2022 in München vom 12. bis 16. September auf rund 50 000 Fachbesucher aus 169 Ländern. Auch wenn die Zahlen einen deutlichen Rückgang zur drinktec 2017 ausweisen (1750 Aussteller/76 000 Fachbesucher) – es war ein hervorragender Neustart für die im vergangenen Jahr abgesagte internationale Leitmesse der Getränkeindustrie.




(BF) Mit einem internationalen Anteil von 65 % bei den Ausstellern und mehr als 70 % bei den Besuchern hat die drinktec ihren Status als Weltleitmesse untermauert. Dr. Reinhard Pfeiffer, Geschäftsführer der Messe München: „Die drinktec zeigt: Weltmessen sind in Europa wieder möglich. Die meisten Besucher kamen aus dem Ausland und davon fast 40 % von außerhalb Europas, wie zum Beispiel aus Mexiko, Brasilien, Südafrika, Japan oder Indien. Bezeichnend, dass das drittstärkste Besucherland nach Deutschland und Italien die USA sind.“
Die VLB Berlin war selbstverständlich auch mit dabei und konnte an ihrem Stand in der
direkt am Eingang gelegenen Halle A6 zahlreiche Mitglieder, Kunden, Ehemalige und Freunde begrüßen sowie viele neue Kontakte knüpfen. „Nach drei Jahren Pause war es für uns eine hervorragende Messe mit vielen guten Gesprächen. Insbesondere das derzeit sehr schwierige wirtschaftliche Umfeld hat viel Diskussionsbedarf erzeugt“, so VLB-Geschäftsführer Dr. Josef Fontaine.
2023 folgt die BrauBeviale
Die nächste drinktec ist für den Herbst 2025 geplant. Im kommenden Jahr wird die BrauBeviale vom 28. bis 30. November 2023 ihre Messehallen in Nürnberg öffnen.
Fotos: (1) Am VLB-Stand in Halle A6 kam keine Langeweile auf / (2) Dr. Josef Pschorr (Personalberater), VLB-Präsident Ulrich Rust (Gerolsteiner), Dr. Josef Fontaine, Ulrich Brendel (Warsteiner), Horst Rademacher (Wilms Supply Chain Technologies), Rainer Schwittay (EDEKA RheinRuhr Stiftung) / (3) Dr. Nils Rettberg, Horst Müller (Efes), Prof. Brian Gibson (TU Berlin), Dr. Josef Fontaine, Wolfgang Janssen (Radeberger Gruppe), Dr. Paul Panglisch / (4) Olaf Hendel, Ulrich Rust, Thomas Lauer, Rudi Wahl (beide Bitburger), Dr. Josef Fontaine / (5) Olaf Hendel, Isara Khaola-iead (Boon Rawd), Dr. Josef Fontaine / (6) Jan Niewodniczanski (Bitburger), Peter Hahn, Dr. Josef Fontaine / (7) Dr. Josef Fontaine mit einer Delegation der East West Brewing Co., Vietnam / (8) Auch die Spirituosenindustrie war vertreten: Wiebke Künnemann (IFGB) und Andreas Büdenbender (Henkell-Freixenet) / (9) Roberto Biurrun empfängt Sarsileap Khieu, Vorstandvorsitzende des neuen VLB-Mitglieds Hanuman Beverages, Kambodscha, mit ihrem Stab / (10) Messebesucher, Peter Peschmann (Veltins), Dr. Stefan Flad, Daniel Schock (Deutscher Brauer-Bund), Dr. Josef Fontaine, Florian Buchhorn (TU Berlin), Dr. Walter Flad, Olaf Hendel
10 Brauerei Forum – Oktober 2022 TECHNIK & TECHNOLOGIE
FACHMESSEN
1 2 3 4






11 Brauerei Forum – Oktober 2022 WIR BRAUEN FÜR DIE BIERE DER WELT Röstmalzbier Malzextrakte Bierkonzentrate Brausirup Braukulöre Flüssige Zucker ASPERA BRAUEREI RIESE GMBH 45478 Mülheim an der Ruhr, Rheinstrasse 146–152 Tel. (02 08) 58 89 80 / aspera@aspera-riese.de www.aspera.de 5 6 7 8 9 10 Fotos: oh/ew
Carlsberg präsentiert neueste Fibre Bottle
Die sogenannte „Fibre Bottle“ geht in der Version 2.0 in eine großangelegte Pilotphase über. Hierbei handelt es sich um die Entwicklung der weltweit ersten Bierflasche aus nachhaltig erzeugten Holzfasern und PEF (Polyethylenfuranoat), die bereits jetzt zu (fast) 100 % biobasiert und vollständig recycelbar sein soll. Die neuartige und biologisch abbaubare Flaschenhülle hat den zusätzlichen Vorteil, dass sie isolierend wirkt und das Bier im Vergleich zu herkömmlichen Dosen oder Glasflaschen länger kühl halten kann.
(F.) In der aktuell laufenden Projektphase werden die neuen Fibre Bottles unter der Marke Carlsberg zum ersten Mal europaweit in die Hände ausgewählter Stakeholder gegeben. Dabei enthalten die neuesten Prototypen Carlsberg-Bier, das mit biologisch und regenerativ angebauter Gerste gebraut wurde. Im Verlauf des Pilotprojekts werden in Deutschland, Dänemark, Schwe -

den, Norwegen, Finnland, UK, Polen und Frankreich insgesamt 8000 Fibre Bottles getestet. Die daraus gewonnenen Erkenntnisse sollen in die nächste Generation des Produktdesigns einfließen. Die Prototypen werden von der dänischen Verpackungsfirma Paboco hergestellt.
Ganz ohne Kunststoff geht es aber doch nicht – PEF
Die äußere Stützhülle der Flasche besteht aus nachhaltig erzeugten und vollständig recycelbaren Holzfasern. Innen ist diese Hülle mit einer dünnen Kunststofffolie aus dem 100 % biobasierten Polymer Polyethylenfuranoat (PEF) ausgekleidet. Entwickelt vom niederländischen Experten für nachhaltige Chemie, Avantium, wird PEF vollständig aus natürlichen Rohstoffen hergestellt. Es soll mit Kunststoffrecyclingsystemen kompatibel sein und kann auch in der Natur abgebaut werden. Neben den Vorteilen einer nachhaltigen Verpackung fungiert PEF als hochwirksame Barriereschicht zwischen dem Bier und der Flaschenaußenhülle. Es soll den Geschmack und die Kohlensäure des Bieres besser als der bislang verbreitetete Kunststoff PET schützen, der auf fossilen Brennstoffen basiert.
Beinahe 100 %ige Recyclingfähigkeit
Die einzige Ausnahme bei der Recyclingfähigkeit der Fibre Bottle stellt aktuell der Flaschenverschluss dar. Gemeinsam mit Paboco und anderen Partnern aus der Paper Bottle Community entwickelt Carlsberg aber bereits alternative Flaschenverschlüsse auf Faserbasis. Hier wird eine generische Lösung für
2023 erwartet. Nach Abschluss der aktuell laufenden und großangelegten Pilotphase will Carlsberg gemeinsam mit Avantium und Paboco die Entwicklung fortsetzen, um eine maßgeschneiderte 3.0-Lösung zu finden.
Gebraut mit unkonventioneller Gerste
Die Innovationen beschränken sich nicht nur auf die Flasche, sondern auch auf deren Inhalt: In Zusammenarbeit mit der Mälzerei Soufflet hat Carlsberg ein Bier mit Gerste gebraut, die vollständig biologisch und regenerativ angebaut wurde. Dieser besondere Gerstenanbau soll nicht nur die Artenvielfalt auf den Feldern, sondern auch die Bodengesundheit fördern und die natürliche Kohlenstoffbindung im Boden im Vergleich zu konventionellen Anbaumethoden erhöhen.
80 % weniger Emissionen als Einwegglas
Die Fibre Bottle in der aktuellen Version schneidet im Vergleich zu einer Einweg-Glasflasche in der Produkt-Ökobilanz deutlich besser ab und soll bis zu 80 % weniger Emissionen verursachen. In der Marktreife strebt Carlsberg einen vergleichbar niedrigen CO2Fußabdruck an wie bei MehrwegGlasflaschen. Diese sind die derzeit umweltverträglichsten Primärverpackungen von Carlsberg-Bieren, sofern sie in effizienten Systemen gesammelt und wiederverwendet werden.
Der Einsatz der Fibre Bottle in großem Maßstab soll das Verpackungsangebot bedürfnisgerecht erweitern und künftig bestehende Verpackungen wie Glasflaschen und Dosen ergänzen.
12 Brauerei Forum – Oktober 2022 TECHNIK & TECHNOLOGIE
NACHHALTIGKEIT
Deutscher Brauer-Bund e.V.
Internet-Plattform


soll Versorgung mit Kohlensäure erleichtern
Der Deutsche Brauer-Bund startet eine Online-Plattform zur Unterstützung von Betrieben der Getränkeindustrie, die aufgrund der Energiekrise mit einem akuten Mangel an Kohlensäure zu kämpfen haben.
(F.) Die neue Internetseite www.co2-plattform.de schafft eine Kontaktmöglichkeit für Anbieter von Kohlensäure auf der einen Seite und für Betriebe auf der anderen Seite, die dringend Kohlensäure für die Produktion oder die Abfüllung benötigen. Die kostenlose Online-Plattform soll allen produzierenden Betrieben aus der Getränkeindustrie offenstehen, unabhängig von Verbandsmitgliedschaften und hergestellten Produkten.
Die Entwicklungen in der europäischen Düngemittelproduktion, die aufgrund der gestiegenen Energiepreise in erheblichem Maß gedrosselt wurde, sind weiter besorgniserregend. Wegen der hohen Energiekosten wurden zahlreiche Anlagen stillgelegt, was neben einem Mangel an Dünger zu einer Verknappung von Kohlensäure bzw. Kohlendioxid (CO2) führt, das bei der Ammoniakherstellung als Nebenprodukt anfällt und in der Ernährungsindustrie für Produktions- und Verpackungsprozesse dringend benötigt wird. Bedeutende CO2-Lieferanten der Lebensmittelwirtschaft haben bereits „höhere Gewalt“ geltend gemacht. Nur noch 30 bis 40 % der üblichen Liefermengen sind derzeit am Markt verfügbar, schätzt der Dachverband der Bundesvereinigung der Ernährungsindustrie (BVE).
Viele mittelständische Brauereien und Abfüller von alkoholfreien Getränken wie auch
Mineralbrunnen oder Fruchtsafthersteller werden aktuell überhaupt nicht mehr mit Kohlensäure beliefert und müssen deshalb ihre Produktion stark einschränken oder ganz einstellen. Die betroffenen Branchen haben bereits in einem gemeinsamen Hilferuf an die Bundesregierung und die EUKommission appelliert, dringend kurzfristige Maßnahmen zu ergreifen, um die Ursache des Engpasses – die explodierenden Energiepreise – und damit die massiven Auswirkungen auf die Lebensmittelproduktion zu beseitigen.
„Mit der neuen Online-Plattform wollen wir kurzfristig eine Kontaktmöglichkeit für die Branche schaffen und in der aktuellen Krise Hilfe zur Selbsthilfe ermöglichen“, erklärt Holger Eichele, Hauptgeschäftsführer des Deutschen Brauer-Bundes (DBB) in Berlin.


In der aktuellen Mangellage suchen immer mehr Unternehmen aus der Brauwirtschaft und anderen Sparten der Getränkeindustrie dringend nach verfügbarer Kohlensäure, während andere Betriebe über Überschüsse aus der eigenen Produktion verfügen oder nicht genutzte Mengen auf Lager haben.
Auf Initiative des DBB und in Zusammenarbeit mit dem Bayerischen Brauerbund wurde innerhalb weniger Tage das neue Portal für betroffene Hersteller etabliert. Die Internetseite ist bewusst datensparsam angelegt und funktioniert wie ein „Schwarzes Brett“. Der DBB hat alle Funktionen vor der Freischaltung rechtlich prüfen lassen, insbesondere mit Blick auf das Kartell- und Wettbewerbsrecht, und dabei von Beginn an auch das Bundeskartellamt als Aufsichtsbehörde einbezogen.
SafBrew™ BR-8

THE FIRST DRY BRETT FOR FLAVORFUL “FUNKIER” BEERS














SafBrewTM BR-8 offers brewers all the flavorful benefits of the “wild” yeast Brettanomyces, but with more control and reliability. Created for secondary fermentation in bottles or casks, SafBrewTM BR-8 provides a finishing touch which evolves over time as the beer is aged, with funkier notes (barnyard, horse, leather…) nicely balanced by refreshing, fruity notes.

13 Brauerei Forum – Oktober 2022
SOON
NEW YEAST COMING
Die Darren haben ein Fassungsvermögen von 400 t
Malzherstellung in Brasilien: Neue Großanlage liefert bis zu 800 Tonnen am Tag

In Brasilien entsteht eine der weltweit größten Anlagen zur Herstellung von Malz. Eine Genossenschaft aus mehreren Unternehmen, unter anderem die Cooperativa Agrária, setzt hier auf die Technologien des Anlagenbauers Zeppelin Systems, der seit mehr als einem Jahrzehnt über das Know-how verfügt, komplette Anlagen für die Malzherstellung zu liefern.
(F.) Der brasilianische Bierkonsum steigt pro Jahr um 3,5 %. Dabei trinken die brasilianischen Verbraucher jetzt schon Bier, das aus 1,75 Mio. t Malz pro Jahr gebraut wird. Bisher hat das Land mehr als die Hälfte der Gerste zur Malzherstellung vor allem aus dem Ausland importiert. Die steigende Nachfrage nach Bier und damit auch nach Gerste und Malz erfordert daher nicht nur eigene Anbauflächen, sondern auch neue Anlagen, die die Masse an notwendigem Malz umsetzen können. Zudem ändert sich das Trinkverhalten der Verbraucher, die immer mehr Biersorten mit hundertprozentigem Malzanteil bevorzugen. Daher ha -
ben sich in Brasilien die Genossenschaften Agrária (aus Guarapuava), Bom Jesus (Lapa), Capal (Arapoti), Castrolanda (Castro), Coopagricola (Ponta Grossa) und Frísia (Carambeí) zusammengeschlossen und bauen die weltweit größte Mälzerei, die je in einem einzigen Projekt errichtet wurde: Maltaria Campos Gerais.
Erweiterung
Diese Anlage soll täglich zwischen 700 und 800 t Malz herstellen. Das entspricht einer Jahresproduktion von etwa 240 000 t Malz und etwa 14 % der Verbrauchernachfrage. Für Agrária ist das die zweite Zeppelin-Anlage dieser
Art, allerdings mit weitaus höherer Kapazität. Die bestehende Anlage kommt aufgrund des sich ändernden Konsumverhaltens an seine Grenzen und kann nicht erweitert werden, da im Umfeld keine freien Agrarflächen mehr vorhanden sind. Das Projekt Maltaria Campos Gerais befindet sich in einem Gebiet, das eine zusätzliche Nutzfläche von 100 000 ha für den Anbau von Gerste bereithält.
Verfahrenstechnik
Schon bei der ersten ZeppelinAnlage setzt Agrária auf die renommierten Technologien dieses Anlagenbauers. Die Qualität der Komponenten, das Gesamtkonzept sowie die verfahrenstechnische Auslegung überzeugte das Unternehmen, sodass sie nun die Großanlage beim selben Anbieter in Auftrag geben. Das MaltariaWerk in Campos Gerais besteht aus einem Weichgebäude mit 24 Weichbehältern, zwei Türmen mit je fünf Keimkästen und zwei Darren sowie peripheren Anlagen. Um die hohen Durchsätze mit gleichbleibend hoher Produktqualität von der Rohstoffannahme bis zur Keimabtrennung zu gewährleisten, bietet Zeppelin Systems verschiedene Lösungen. So sorgt zum Beispiel das Becherwerk für eine produktschonende, vertikale Förderung der Gerste in die Waage. Die automatischen Waagen von Zeppelin Systems ermöglichen eine präzise Verwiegung und der Anwender hat stets alle Parameter im Blick, sodass die exakte Menge an Gerste dem Produktionsprozess zugeführt wird und im Anschluss
14 Brauerei Forum – Oktober 2022 TECHNIK & TECHNOLOGIE
Foto/Abb.: Zeppelin
Zeppelin Systems
der Weichprozess beginnen kann. Hier wird die Gerste so lange befeuchtet, bis sie zu keimen beginnt.
Keimen und Darren
Der Keimvorgang ist ein elementarer Prozessschritt jeder Mälzerei. Die Anlage Maltaria Campos Gerais hat zehn runde Keimkästen, die auf zwei 65 m hohe Betontürme verteilt sind und einen Durchmesser von 30,5 m sowie ein Fassungsvermögen von jeweils 400 t Gerste haben. Diese Zeppelin-Technologie sorgt für das Handling großer Volumina, was für Agrária elementar ist, da die Großanlage an 365 Tagen Malz produzieren wird. In der Keimanlage wird die Gerste kontinuierlich befeuchtet, indem Luft durchströmt und dafür sorgt, dass die Gerste nicht austrocknet. Hinzu kommen zwei kreisförmige Darren mit einem Durchmesser von 40 m und einem Fassungsvermögen von 400 t Gerste. Die Darren befinden sich in angrenzenden Gebäuden. Auch beim Rösten ermöglichen die Anlagen, differenzierte
Geschmacks- sowie Optikprofile zu generieren und so den Charakter des späteren Endprodukts gezielt zu beeinflussen. Zwischen den beiden Darren kommen eine Wärmerückgewinnung sowie Automatisierungslösungen zum Einsatz, die für einen extrem effizienten Ablauf sorgen.


Alles in allem ist für die Anlage Maltaria Campos Gerais die hohe Qualität der Komponenten und ein reibungsloser Ablauf der einzelnen Prozessschritte elementar. Denn die Brauereien haben bereits einige Großaufträge in Brasilien geplant, die aktuell für eine Vollauslastung der Anlage sorgen.
Nachhaltiges Wirtschaften
Neben Effizienz und Profitabilität hat das Thema Nachhaltigkeit bei Agrária einen hohen Stellenwert. Daher besitzt die Anlage Wärmetauscher zur Rückgewinnung der in der Produktion anfallenden Wärme. Dies erzielt eine Energieeinsparung bis zu 20 %. Zudem reduziert die eingesetzte Technologie
den Wasserverbrauch. Die Investition in das Thema Nachhaltigkeit bringt international vor allem gute Partnerschaften hervor, da die Abnehmer – große Weltkonzerne –ebenfalls einen starken Fokus auf dieses Thema legen. Cooperativa Agrária ist bei der Sustainable Agriculture Initiative Platform (SAI) gelistet und auf 20 % Gold- sowie 80 % Silber-Niveau gerankt. Die SAI setzt sich für den Aufbau eines nachhaltigen Agrarsektors ein und legt Wert auf starke sowie sichere Lieferketten.
Die neue Anlage Maltaria Campos mit einer Kapazität von 700 bis 800 t Malz täglich
15 Brauerei Forum – Oktober 2022
Reinzuchthefen & Starterkulturen Hefestämme und funktionelle Mikroorganismen für die Brauerei, die Spirituosen- und Getränkeindustrie www.vlb-berlin.org/hefe VLB Berlin – Biologisches Labor Seestraße 13, 13353 Berlin biolab@vlb-berlin.org + obergärige Hefestämme + untergärige Hefestämme + Hefen für alkoholarmes Bier und Spezialbiere (z.B. Sauerbier) + Brennerei-, Wein- und Champagnerhefen + Milchsäurebakterien zur biologischen Säuerung + Kulturen für alternative Gärgetränke (z.B. Kombucha oder Wasserkefir) Versand als Schrägagar oder Hefekonzentrat
Die Aufgaben stellte Andreas Großmann, Staatliche Berufsschule Main-Spessart
BRAUER-SCHULE
Fachfragen und Fachrechnen für Auszubildende
Hefemanagement
Die Hefe spielt eine sehr wichtige Rolle in der Brauerei, denn sie wandelt verschiedene Zucker in Alkohol und CO2 um und bringt durch ihre Gärungsnebenprodukte verschiedene Aromen ins Bier. Deshalb muss der Umgang mit ihr auch sorgfältig „gemanagt“ werden.
1. Unter Hefemanagement versteht man…
a) den Umgang mit Kulturhefen in der Hefebank. b) den Prozess von Hefeherführung über Hefegabe bis zur Hefelagerung. c) den Vorgang des Hefewaschens nach der Hefeernte. d) die Suche nach neuen Hefestämmen. e) den Prozess der Reinzucht von Hefezellen.
2. Welcher der folgenden Begriffe passt nicht zum Oberbegriff „Hefemanagement“?
a) Hefereinzucht b) Carlsberg-Kolben c) Assimilationstank d) Hefepropaganda e) Hefeernte
3. Brauereien können ihre Hefe aus anderen Brauereien beziehen oder durch Reinzucht selbst „herführen“. Dabei spielt die Hefepropagation eine zentrale Rolle. Was ist „Hefepropagation“? a) Zucht von neuen Hefestämmen mithilfe von Glucose. b) Intensive Vermehrung von Hefe in Würze mithilfe von getakteter Belüftung. c) Konservierung von Hefezellen mithilfe von flüssigem Stickstoff. d) Intensive Vermehrung von Hefe mithilfe von Aminosäuren. e) Intensive Vermehrung der Hefe mithilfe von Fettsäuren und Zink.


4. Als Hefegabe bezeichnet man die Zugabe von Hefe beim Anstellen. Die optimale Anstellhefe sollte besondere Eigenschaften aufweisen. Welche zählt nicht dazu? a) dickbreiige Konsistenz b) Anzahl toter Hefezellen höchstens 3 % c) hohe Vitalität d) schnelle Umschaltung auf Gärung e) hohe Gärkraft
5. Um die Anstellhefe aufzubewahren, zu transportieren und in die Würze zu geben, wurden früher sog. Hefebirnen eingesetzt. Diese ist nur eines der vielen Gefäße und Geräte, die im Hefemanagement eingesetzt werden. Ein weiteres ist der Carlsberg-Kolben. Der Carlsberg-Kolben ist… a) ein Hefestutzen b) eine spezielle Hefepumpe
c) ein Belüftungselement d) ein kleines Gefäß zur Hefepropagation e) ein Reagenzglas mit Schrägagar
6. Während der Hauptgärung setzt sich die Hefe am Boden des Gärgefäßes ab. Einer der nächsten Schritte ist die Gewinnung der „Erntehefe“, die wiederum neu „geführt“ werden kann. Doch bevor die Hefe wieder „geführt“ wird, sollte sie behandelt werden. Welche Behandlung ist nicht geeignet?
a) Die Hefe wird belüftet, um das CO2 auszutreiben. b) Die Hefe wird gewaschen, um den Trub zu entfernen. c) Die Hefe wird gesiebt, um u.a. das CO2 auszutreiben. d) Die Hefe wird bei 0 bis 3 °C aufbewahrt, um ihre Stoffwechselvorgänge zu minimieren. e) Die Hefe wird unter warmem Wasser gelagert, um ihren Stoffwechsel anzuregen.
7. Die Hefe durchläuft vom Anstellen bis zur Ernte verschiedene Stadien. Sie kann von aerobem zu anaerobem Stoffwechsel umstellen. Unter besonderen Bedingungen kann die Hefe auch autolysieren. Hefeautolyse bedeutet, die… a) Umstellung von Atmung auf Gärung bei Sauerstoffmangel. b) Abtrennung der Tochterzelle von der Mutterzelle während der Sprossung. c) Selbstzersetzung der Hefezellen bei Nahrungsmangel. d) Sporenbildung der Hefezellen bei Nahrungsmangel. e) Kreuzkontamination mit anderen Heferassen.
Fachrechnen
Wie viel Hefe benötigt man, wenn ein zylindrokonischer Gärtank mit Anstellwürze befüllt wird und pro hl Anstellwürze 0,8 l dickbreiige Hefe gegeben werden sollen? (volle l)
Der Tank weist folgende Maße auf:
Durchmesser: 2,0 m
Gesamthöhe: 5,0 m
Konushöhe: 1,2 m
Zusätzlich soll im Tank ein Steigraum von 80 cm für die Schaumbildung gelassen werden.
16
Forum – Oktober 2022 TECHNIK & TECHNOLOGIE
Brauerei
(Lösungen S. 31)
Foto: VLB Berlin
50 Jahre Partyfass – das Minikeg hat Geburtstag

Es ist rund, aus Weißblech gefertigt und enthält einen integrierten Zapfhahn – das 5-Liter-Fass ist eine echte Erfolgsgeschichte und in diesem Jahr 50 Jahre alt geworden. Über 26 Mio. verkaufte Fässchen im Jahr 2021 beweisen, dass Envases Öhringen ein Produkt geschaffen hat, das durch Innovation und Weiterentwicklung mittlerweile weltweit verkauft wird. Das Minikeg bietet dem Konsumenten die Möglichkeit, zu Hause ein frisch gezapftes Bier zu genießen – gerade in Zeiten von Corona ein echter Vorteil. Das zeigt auch das Umsatzplus von mehr als 10 %, das das Fass während der vergangenen drei Jahren verzeichnet hat.
(F.) 1972 entwickelte Otto Meister, der Enkel des Firmengründers Karl Huber, im Baden-Württembergischen Öhringen das erste kleine Bierfass mit einem Volumen von fünf Litern. Damit waren die damaligen Huber Verpackungswerke der erste Weißblechverpackungshersteller der Welt, der einem zylindrischen Dosenkörper die charakteristische Fassform gab. Ein sog. Expandierleisten spreizte das Fass von innen heraus und gab ihm die gewölbte Form. Das Verfahren blieb bis heute gleich, wurde allerdings in den vergangenen fünf Jahrzehnten optimiert.
Ein Meilenstein in der Geschichte des Partyfasses wurde 1998 erreicht: Passend zur FußballWeltmeis terschaft wurde das 5-Liter-Fass mit integriertem Zapfhahn erfunden. "Zapfen wie die Weltmeister" hieß die groß angelegte Marketing-Kampagne zur Markteinführung. Sie war ein riesiger Erfolg und die Basis für den weltweiten Export der neuen Minikegs auf fünf Kontinente.
fassbier@home
"Wir sind sehr stolz, dass unser 5-Liter-Fässchen bei all unseren Kunden so beliebt ist“, freut sich Peer Brämer, Vertriebsleiter bei Envases. „Es ist egal, ob es sich um große Brauerei-Konzerne handelt oder um kleine feine CraftbierBrauereien – mit dem Minikeg kann jeder Kunde seine Marke in Szene setzen. Envases sieht sich hier auch als Partner, der berät, beim Layout unterstützt und die Fässchen fertig bedruckt liefert.“
Insbesondere in der Pandemie-Zeit hat sich das 5-l-Fass bewährt: Viele Gaststätten waren geschlossen,
Events wurden abgesagt, aber das kleine Fässchen konnte weiter verkauft werden. Mit dem Slogan ‚fassbier@home‘ setzte Envases auf die Feier mit Freunden und Familie und die Lust der Menschen nach einem frisch gezapften Bier. Das Partyfass war bestens geeignet, Lebensfreude und gemeinsames Feiern in den eigenen vier Wänden zu einem echten Highlight zu machen. Die Konsumenten haben diese Einladung verstanden und der Umsatz mit dem Minikeg konnte sich in einigen Ländern von 2019 auf 2021 um mehr als 10 % steigern.
Die Beliebtheit des Partyfasses zeigt sich nicht nur in den Umsatzzahlen, sondern auch in vielen nationalen und internationalen Auszeichnungen. So hat das 5-Liter-Fass bereits vier Mal eine Auszeichnung
beim renommierten "Cans of the Year Award" erhalten. 100 Prozent recycelbare nachhaltige Metallverpackungen – dafür steht Envases am Standort Öhringen seit 150 Jahren. Gegründet und im Markt als HUBER Packaging Group bekannt, gehört das Unternehmen mit fast 700 Mitarbeitenden seit 2021 zur Envases Europe A/S mit Sitz in Dänemark. Die Envases Group beschäftigt an 71 Standorten auf vier Kontinenten 10 000 Mitarbeitende. Die Produkte gliedern sich in zwei Segmente: Industrial & Beverage. Zu Letzterem gehört auch das Fünf-Liter-Fass. Mit dem Minikeg ist Envases seit Jahren unangefochtener Weltmarktführer, über 1000 Marken und Biersorten wurden bereits im Fünf-Liter-Fass abgefüllt.
17 Brauerei Forum – Oktober 2022 Envases
IfGB-FORUM VERBÄNDE
BSI
Spirituosenkonsum im internationalen Vergleich
Deutschland im Mittelfeld. Höchster Konsum in Südkorea. Für viele Deutsche ist der gelegentliche Genuss einer guten Spirituose ein Stück Lebensqualität. Im Schnitt trinken sie pro Kopf 4,9 L im Jahr.
Seiten aus der BSI-Broschüre „Daten aus der Alkoholwirtschaft“
ALKOHOLWIRTSCHAFT
(F.) Damit liegt Deutschland im europäischen Mittelfeld. Dies zeigt die Rangliste, die der Bundesverband der Deutschen Spirituosen-Industrie und -Importeure e. V. (BSI) in seiner Broschüre „Daten aus der Alkoholwirtschaft“ veröffentlicht. Deutlich mehr Spirituosen als hierzulande werden in vielen osteuropäischen Ländern getrunken. Mit einem ProKopf-Verbrauch von 15,0 L führt Belarus die Liste an. Auf den Plätzen 2 und 3 folgen Lettland mit 11,8 und Estland mit 10,8 L. Dies zeigen Zahlen, die der BSI unter Hinweis auf das britische Marktforschungsinstitut IWSR publiziert hat. Nicht viel weniger wird demnach in Bulgarien (10,5 L), Litauen (10,2 L), Polen
(9,3 L) und Russland (9,0 L) getrunken. Selbst „Spitzenreiter“ Belarus reicht allerdings bei weitem nicht an Südkorea heran, das mit stattlichen 25,2 L weltweit die Tabelle anführt. Vergleichbare Zahlen wie Deutschland zeigen innerhalb Europas unter anderem Tschechien mit 5,0 L sowie Frankreich mit 4,9 L und Großbritannien mit 4,8 L pro Person und Jahr. Weltweit liegen unter anderem Kanada (4,9 L) und China (5,3 L) auf dem Niveau der Bundesrepublik. Hingegen ist der Konsum innerhalb der Nachbarländer der DACH-Region keineswegs einheitlich: Die Österreicher und Schweizer trinken mit 2,9 und 2,7 L auffällig weniger Spirituosen als die Deutschen. Ähnlich niedrig liegt der Verbrauch in Skandinavien: Norwegen (2,9 L) und Schweden (2,6 L) sowie in Griechenland (2,4 L). Die Schlusslichter in Europa bilden zum einen stark islamisch geprägte Länder wie der Kosovo (1,7 L), Aserbaidschan (1,1 L) und die Türkei (0,8 L), zum anderen auch südeuropäische wie Italien und Portugal mit jeweils 1,7 L. Noch weniger Spirituosen werden in vielen Ländern Asiens und Afrikas konsumiert wie Irak, Vietnam oder Äthiopien. Die letzten Listenplätze teilen sich mit je 0,2 L Malaysia und Kamerun.
DATEN AUS DER ALKOHOLWIRTSCHAFT SEITE 36 Spirituosenkonsum weltweit 2020 (Angaben in Liter Fertigware pro Kopf der Bevölkerung) Land Konsum pro Kopf Land Konsum pro Kopf
FACHLITERATUR
Daten aus der Alkoholwirtschaft 2022

Bundesverband der Deutschen Spirituosen-Industrie und -Importeure e. V. (BSI), Bonn (Hg.): 72 S., zahlreiche Tabellen und Statistiken, kart. DIN A6, 2022, info@bsi-bonn.de.
(F.) Welche Spirituosen trinken die Deutschen am liebsten? Was sind die wichtigsten Vertriebswege? Wie viel Geld nimmt der Staat an Alkoholsteuern ein? Diese und andere Fragen rund um den Spirituosen- und Alkoholmarkt beantwortet die Broschüre „Daten aus der Alkoholwirtschaft 2022“, die der BSI jüngst veröffentlicht hat. In der jährlich erscheinenden Datensammlung trägt der Verband alle relevanten Zahlen – von der Anzahl und Größe der Betriebe über die Marktanteile verschiedener Kategorien bis zu den Werbeausgaben der Branche übersichtlich zusammen. Die „Spirituosen-Hitparade“ bietet einen schnellen Überblick über Absatz und Umsatz verschiedener Kategorien. Ein separater „Sonderteil Europa“ gibt Auskunft unter anderem über den internationalen Spirituosenkonsum, den Export deutscher Spirituosen in die Europäische Union sowie die Alkoholsteuersätze in den EULändern.
Kostenfreier Download/Versand: www.spirituosen-verband.de
18 IfGB AKTUELL Brauerei Forum – Oktober 2022
Spirituosenkonsum
(Angaben in Liter Fertigware pro Kopf der Bevölkerung) Land Konsum pro Kopf Land Konsum pro Kopf 1.
2.
3.
4.
5.
6.
7.
8.
9.
10.
11.
12.
13.
14.
15.
16.
17.
18.
19.
20.
21.
22.
23.
24.
25. Japan
26. Slowakische
27. Réunion
28. Ukraine
29. Nördliche
30.
31. Vereinigte
32. Bahamas
33. Serbien
34. Turks-
35. Philippinen
36. Sri Lanka
37. Montenegro 5,8 38. Trinidad und
5,8 39. Kasachstan 5,5 40. China 5,3 41. Ungarn 5,3 42. Kuba 5,2 43. St. Kitts 5,1 44. Tschechische Republik 5,0 45. Frankreich 4,9 46. Usbekistan 4,9 47. Kanada 4,9 48. BR Deutschland1) 4,9 49. Kirgisistan 4,8 50. Vereinigtes Königreich 4,8 51. Französisch-Guyana 4,8 52. Rumänien 4,8 53. Malta 4,6 54. Suriname 4,5 55. Finnland 4,2 56. Guyana 4,2 57. Dominikanische Republik 4,0 58. Irland 4,0 59. Armenien 4,0 60. Haiti 4,0 61. Brasilien 3,9 62. Nicaragua 3,8 63. Jamaika 3,8 64. Australien 3,6 65. Dänemark 3,5 66. Kroatien 3,5 67. Macau 3,4 68. Georgien 3,4 69. Äquatorialguinea 3,3 70. Puerto Rico 3,3 71. Paraguay 3,3 72. Kanarische Inseln 3,2 73. Zypern 3,2 74. Niederlande 3,1 75. Chile 3,1 76. Belgien/Luxemburg2) 3,0 77. Österreich 2,9
78.
79.
80.
81.
82.
83.
84.
85.
86.
87.
88.
89.
90.
91.
92.
93.
94.
95.
96.
97.
98. Argentinien
99.
100. Italien
101. Kosovo
102. Portugal
103.
104.
105.
106.
107.
108.
109.
110.
111.
DATEN AUS DER
SEITE 35
weltweit 2020
Republik Korea 25,2
Amerikanische Jungferninseln 17,5
Belarus 15,0
St. Martin und St. Maarten 15,0
Kaimaninseln 11,9
Lettland 11,8
St. Lucia 11,5
Curaçao 11,3
Estland 10,8
Bulgarien 10,5
Litauen 10,2
Britische Jungferninseln 9,7
Thailand 9,7
Polen 9,3
St. Vincent 9,0
Russische Föderation 9,0
Bermuda 9,0
Barbados 8,6
Aruba 8,4
Martinique 8,1
Mauritius 8,1
Antigua und Barbuda 8,0
Grenada 7,8
Guadeloupe 7,8
7,8
Republik 7,8
7,7
7,4
Emirate 7,4
Seychellen 7,1
Staaten 6,9
6,8
6,7
und Caicosinseln 6,6
6,2
6,0
Tobago
Norwegen 2,9
Spanien 2,8
Neuseeland 2,7
Schweiz 2,7
Moldawien 2,7
Schweden 2,6
El Salvador 2,5
Uruguay 2,5
Albanien 2,4
Griechenland 2,4
Island 2,3
Mexiko 2,2
Myanmar 2,2
Slowenien 2,1
Costa Rica 2,1
Ghana 2,1
Israel 2,0
Südafrika 2,0
Honduras 2,0
Indien 1,9
1,8
Venezuela 1,7
1,7
1,7
1,7
Taiwan 1,7
Panama 1,6
Angola 1,6
Hong Kong 1,6
Turkmenistan 1,6
Nordmazedonien 1,6
Katar 1,5
Bahrain 1,4
Belize 1,3 112. Kolumbien 1,3 113. Bosnien und Herzegowina 1,2 114. Kenia 1,2 115. Guatemala 1,2 116. Aserbaidschan 1,1 117. Libanon 1,0 118. Bolivien 1,0 119. Abu Dhabi 1,0 120. Gabun 1,0 121. Nigeria 1,0 122. Dubai 0,9 123. Ecuador 0,9 124. Peru 0,9 125. Singapur 0,9 126. Republik Kongo 0,8 127. Namibia 0,8 128. Türkei 0,8 129. Tadschikistan 0,7 130. Uganda 0,6 131. Kambodscha 0,6 132. Irak 0,6 133. Tansania 0,5 134. Republik Sambia 0,5 135. Côte d’Ivoire 0,4 136. Oman 0,4 137. Botsuana 0,3 138. Vietnam 0,3 139. Togo 0,3 140. Dschibuti 0,3 141. Mosambik 0,3 142. Äthiopien 0,3 143. Jordanien 0,3 144. Malaysia 0,2 145. Kamerun 0,2 1) Analyse des ifo Instituts – Leibniz-Institut für Wirtschaftsforschung an der Universität München: Pro-Kopf-Verbrauch für Spirituosen 2020: 5,2 Liter Fertigware – vgl. Seite 10 2) Einschließlich Grenzverkehr Quelle: the IWSR and the IWSR Magazine (the Source for Wine & Spirits Analysis)
20. IfGB-Forum: „Krisen bedeuten für uns Herausforderung und Umdenken“
Das 20. IfGB-Forum Ende September im Münsterland war mit rund 100 Entscheidern und Experten der Spirituosenbranche sehr gut besucht. Trotz der Krisen herrschte Aufbruchsstimmung. Der Themenkreis spannte den Bogen von den Rahmenbedingungen bis hin zu erfolgreichen Getränketrends wie alkoholfreien Destillaten und RTD in Dosen. Aber auch Nachhaltigkeit, Technologie und Logistik kamen nicht zu kurz und wurden auf den spannenden Betriebsbesichtigungen bei der Euro-Alkohol (eal) und der Sasse Feinbrennerei sehr anschaulich illustriert.

(WiK) „Als Kornbrennerei mit 333-jähriger Unternehmensgeschichte betrachten wir auch die aktuellen Krisen aus anderer Perspektive“, sagte Moderator Kai Elmendorf aus der gleichnamigen Brennerei. „Es ist schwierig – aber es geht weiter.“
Am ersten Tag sprach VLB-Geschäftsführer Dr. Josef Fontaine über die jüngsten Entwicklungen am Campus Seestraße, die z.T. ganz neue Perspektiven bieten. Ob mit dem neuen Leiter der Spirituosenanalytik Tim Fuchs oder mit den neuen Inhabern der Preussischen Spirituosen Manufaktur.
Der Spirituosenexperte des Bundesministeriums für Ernährung und Landwirtschaft, Werner Albrecht, stellte die Neuerungen der Spirituo -
sen-Verordnung vor: „Genau zu dieser Stunde wird in Brüssel über neue Kategorien verhandelt.“ Zusätzlich präsentierte er in einem separaten Vortrag die Geschichte der Kornbrennereien des Münsterlandes. BSI-Geschäftsführerin Angelika Wiesgen-Pick merkte in Ihrem Vortrag an: „Wir hatten nach Corona auf eine bessere Zeit gehofft.“ Mit Blick auf den Mitarbeitermangel in der Gastronomie sagte sie: Gastroprobleme sind auch Spirituosenprobleme.“
Theo Ligthart, Freimeisterkollektiv, ging auf sein früheres Projekt „Das Korn“ ein, das bereits vor 15 Jahren einen neuen Blick auf diese Kategorie lenkte. „Schicksalsschläge führen zu einer Neuausrichtung“, betonte Rüdiger Sasse von der gleich -
namigen Brennerei. Er zeigte, wie er mit fassgelagertem Korn, aber auch mit seiner „Nju-Korn“-Linie mit sehr unterschiedlichen Getreidenoten ganz neue Geschmackserlebnisse erzielt. Dr. Bernhard Strotmann sagte in Bezug auf Wiesgen-Picks Vortrag: „Ich bin ganz positiv gestimmt. 18- bis 30-jährige kaufen Korn, Korn verdrängt Wodka...“ Besondere Highlights waren die Betriebsbesichtigungen in Schöppingen und Lüdinghausen. Der anschließende Begrüßungsabend in Coesfeld bot weitere Möglichkeit zum Meinungs- und Gedankenaustausch. Am zweiten Tag gab es viel Stoff für Diskussionen, sodass Teilnehmer und Veranstalter sehr zufrieden ihre Heimreise antraten. Der ausführliche Tagungsbericht folgt
Mit Unterstützung von
19 Brauerei Forum – Oktober 2022
TAGUNGEN
Foto: WiK
GGBW
VERBÄNDE
GGBW-Vorstand zu Besuch auf der Mitgliederversammlung der Gesellschaft für die Geschichte des Brauwesens in Stralsund
Am 23. und 24. September tagte die GGB mit mehr als 80 Teilnehmern bei der Störtebeker Brauerei in Stralsund. Zum ersten Mal mit von der Partie waren Vorstandsmitglieder der Gesellschaft für Geschichte des Branntweins e.V. (GGBW) – ein weiterer Meilenstein im KennenlernProzess beider Geschichtsvereine.


(WiK) Am Nachmittag des 23. Septembers trafen sich Mitglieder und Gäste der GGB im Hof der Störtebeker Brauerei in Stralsund. Zügig ging es auf eine sehr spannende Brauereiführung, die zeigte, wie gut man Tradition und Moderne verbinden kann. Im Anschluss traf man sich im Veranstaltungsraum „Kühlschiff“, im historischen Teil der Brauerei. Dr. Josef Fontaine , Vorsitzender der GGB, eröffnete die Veranstaltung, bedankte sich beim Brauerei-Inhaber Jürgen Nordmann für die große Gastfreundschaft und begrüßte besonders die vom Vorstand der GGBW angereisten Gäste.
Beginn der Brauereiführung
Gäste der GGBW: Geschäftsführer Werner Albrecht, Vorstand Wiebke Künnemann, Präsident Alois Gerig
Zwei sehr spannende Fachvorträge leiteten den Abend ein. Jürgen Nordmann skizzierte den Weg von der Stralsunder Brauerei zur Störtebeker Braumanufaktur Die dazu gehörende Störtebeker Brennerei auf Rügen glänzt mit Whiskys, Geisten und Likören. Brau- und Malzmeister Bernd Birkenstock schilderte anschließend entlang seines Brauerlebens die Entwicklung der Qualitätssicherung in der Brauerei Um 18.30 Uhr eröffnete Dr. Fontaine die vom GGB-Geschäftsführer Alexander Hofmann moderierte Mitgliederversammlung. Anschließend
be dankte sich GGBW-Präsident Alois Gerig für die Einladung. „Wir sind die kleine Schwester der GGB. Wir wollen von Euch lernen“, sagte er. „Ich bin begeistert von all dem, was die GGB bereits geschaffen hat. Zum Sommerfest der VLB durfte ich deren Laboratorien besichtigen, aber auch die Institutsbibliothek mit der Schultze-Berndt-Bibliothek der GGB – dort stehen auch viele für die Branntweingeschichte wichtige Werke.“ Abschließend sprach Gerig die Gegeneinladung für den GGB-Vorstand zur GGBWMitgliederversammlung 2023 in der Hallertau aus. Der Tag klang mit Fachsimpeleien bei Störtebeker Bier aus. Der Samstag startete mit einer historischen Stadtführung, die in das gemeinsame Mittagessen im mittelalterlichen Scheele-Haus mündete. „Eine perfekt organisierte Veranstaltung“, lobte GGBWVorstandsmitglied Wiebke Künnemann. „Ich bin begeistert, wie viele Archäologinnen, Historiker, Journalistinnen und Getränketechnologen mit tiefgründigem historischen Wissen ich hier getroffen habe.“
Der ausführliche Bericht der Gesellschaft für Geschichte des Brauwesens folgt im Novemberheft
Die Geschichte der Haselünner Kornbrennereien
Dieter Kronabel: Die Geschichte der Haselünner Kornbrennereien von den Anfängen bis zum großen Stadtbrand 1849, 77 S., zahlreiche z.T. farbige Abbildungen und Faksimiles. 256 x 216 mm, kart., Machandel Verlag, Haselünne 2021, ISBN 978-3-95959-343-4, 24,90 €.


Die Einleitung skizziert die Geschichte der Destillation von den Anfängen 3000 v.Chr. bis zur Produktion von Kornbranntwein ab Ende des 15. Jhs. Mit Beginn der Neuzeit ließ die Versorgungslage mit Getreide im Emsland zu, Getreidebranntwein herzustellen, und so startete Anfang des 16. Jhs. auch die Kornbrennerei in Haselünne. Alle drei noch aktiven Kornbrennereien haben das Werk unterstützt: Berentzen, Heydt und Rosche.
Kronabel skizziert jahrhundertweise die Entwicklung der Kornbrennereien in Haselünne und stellt diese in den Kontext der Stadt- und Landesgeschichte. Eine gelungene, kompakte Darstellung einer sechs Jahrhunderte dauernden Geschichte. GGBW-Präsident Alois Gerig betont in seinem Grußwort: „Wenn man eine Liste der wichtigsten Kulturgüter der Stadt Haselünne erstellen müsste, wären für mich die Kornbrennereien und der Korn ganz vorne mit dabei.“
Der Anhang zeigt Fotos aus dem Brennereimuseum „Berentzen Hof“ sowie aus der Haselünner Edelkorn-Brennerei Jos. Rosche.
20 IfGB AKTUELL Brauerei Forum – Oktober 2022
GGB / GGBW
FACHLITERATUR Fotos: WiK
Obstbrennertag in Berlin: Brenner und Politiker im Dialog

Am 22. September folgten rund 40 geladene Gäste der Einladung des Bundesverbands der Deut schen Klein- und Obstbrenner in das Haus der Ernährungs- und Landwirtschaft, Berlin. Grußworte von hochkarätigen Politikern und Verbandsvertretern eröffneten einen Abend für konstruktive Diskussionen.
(WiK) Alois Gerig, 1. Vorsitzender des Bundesverbands und ehemaliger Vorsitzender des Landwirtschaftsausschusses des Deutschen Bundestags, eröffnete den Abend. Er skizzierte die massiven Umstrukturierungen nach Ende des Branntweinmonopols und die Herausforderungen, die die Kleinbrenner bis heute belasten. Er würdigte die Leistungen der Brenner in Sachen Qualität, aber auch im Bereich der Pflege und des Erhalts der Streuobstwiesen. „Am Ende geht es in unserer Branche auch immer um Genuss und Begeisterung“, schloss Gerig.

Streuobstwiesen – Korallenriffe
Die Parlamentarische Staatssekretärin Dr. Ophelia Nick hob die Bedeutung der Kleinbrenner für den Erhalt und die Pflege der Streuobstwiesen und den damit geleisteten Beitrag zum Sorten- und Artenschutz hervor. „Streuobstwiesen sind, bezüglich der Artenvielfalt, Korallenriffe an Land“, begeisterte sich die promovierte Tierärztin. Auch für die Forderung der Obstbrenner nach einer Aufstockung ihrer Kontingente, zeigte sie großes Verständnis. Bei der Frage nach der Deklaration

des Zutatenverzeichnisses bezog sie allerdings klare Position. „Transparenz und Verbraucherschutz sind für uns sehr wichtig. Das Zutatenverzeichnis muss auch denen zugänglich sein, die mit dem Internet nicht so vertraut sind. Daher fordern wir die Deklaration auf dem Etikett.“
Schützen durch nützen
Hermann Färber, Vorsitzender des Landwirtschaftsausschusses des Deutschen Bundestages, ging auf die Pflege der Streuobstwiesen ein. Das Prinzip „schützen durch nützen“ sei von den Kleinbrennern aufs Beste umgesetzt. Da sie das Obst für ihre Brände nutzen, engagieren sie sich mit ihrer Arbeit für den Schutz der Streuobstwiesen. So funktioniere Umweltschutz – nicht durch immer mehr Ge- und Verbote. „Lassen Sie uns den Abend nutzen, um einander kennzulernen und die unterschiedlichen Standpunkte in Ruhe zu diskutieren“, regte der CDU-Politiker an.
Situation der Abfindungsbrenner
Gerald Erdrich, Geschäftsführer des Bundesverbands der Klein- und Obstbrenner skizzierte die Situation der Abfindungsbrennereien und
Stoffbesitzer in Deutschland. Steuererleichterungen gibt es für Kleinbrenner (mit einem Kontingent von max. 300 L reinen Alkohols pro Jahr) und Stoffbesitzer (Privathaushalte mit Obstbäumen, deren Früchte sie von Kleinbrennern zu Bränden verarbeiten lassen). Aktuell gibt es noch 23 000 Brennerlaubnisse, von denen aber nur rund 14 000 aktiv seien. Erdrich ging auf die produzierten Alkoholmengen und dafür gezahlten Steuern ein. Neben dem Beitrag zum Umweltschutz verwies er auch auf die Zulieferer, die von den Kleinbrennern leben. Das Kontingent liegt seit fast 100 Jahren bei 300 L.A. Energiekosten, Kosten für Brenngeräte etc. haben sich seitdem sehr stark gesteigert. Der Verband fordert daher eine Erhöhung des Brennkontingents auf 500 L.A. In einem waren sich alle Redner einig: Die Leistung der Obst- und Kleinbrenner ist unterstützenswert – sowohl was die Pflege und den Erhalt der Streuobstwiesen angeht als auch den Beitrag zu Obstbränden als Kulturgut. Der Abend schloss mit angeregten Gesprächen, auch mit Obstbränden und daraus bereiteteten Cocktails.
21 Brauerei Forum – Oktober 2022 Nachrichten aus dem Institut für Gärungsgewerbe und Biotechnologie zu Berlin
VERBÄNDE
Fotos: WiK
Dr. Ophelia Nick, Die Grünen
Hermann Färber, CDU
BRAU-BÖRSEN-BILANZ
Was bringt das 2. Halbjahr 2022?
Nach kurzer Erholung gingen die deutschen Börsenbarometer am 31. August auf dem Niveau des Halbjahresultimos 2022 aus dem Markt. Der Dax 40 (FAZ-Index) schloss bei 12 835 (2086) Punkten, eine Veränderung von +0,4 (-0,3) %.
Am 1. September 2022 lag der EZBKurs für 1 € bei noch 1,0004 US-$, die Euro-Inflationsrate bei 9,10 % und die Umlaufrendite unserer Bundesanleihen bei durchschnittlich 1,50 %.
Kulmbach-Absatz: Bier leichter, AfG sehr fest Im Konzern der Kulmbacher Brauerei AG stellte sich der Bierabsatz im 1. Halbjahr 2022 (2021) ohne Lohnfertigung um -0,8 % auf 1,258 (1,268) Mio. hl. Die Oberfranken wiesen auf ihren im Vergleich zur Branche höheren Absatzanteil im Handel hin. Der LEH sei bei Bier rückläufig gewesen: Heimkonsum gehe zurück in die Gastronomie. So habe Bügelverschluss„Mönchshof“ im LEH verhalten tendiert, insgesamt aber weitere Wachstumsimpulse gesetzt. Gelobt wurden „Kulmbacher Edelherb“ sowie „Keiler Helles“ und dito „Kellerbier“ aus Würzburg. Für Stabilität hätten die alkoholfreien Biere und Biermischgetränke gesorgt, auch wertmäßig. Der AfG-Absatz kletterte hingegen +8,4 % auf 0,491 (0,453) Mio. hl dank Normalisierung bei Sport, Veranstaltungen und Schulbetrieb. Für „Bad Brambacher“ wurden +15,8 % genannt (dabei „Garten-Limonade“ +26,8 %). Insgesamt hat die Plassenburg ihre Getränkeverkäufe +1,6 % auf 1,749 (1,721) Mio. hl steigern können.
nach 45,7 Mio. €), deutlich stärker erhöhten sich Personalaufwand und sonstige betriebliche Aufwendungen (dort vor allem für Vertrieb und Marketing). Das Betriebsergebnis stieg auf 7,85 (5,65) Mio. €. Nach -0,3 (-0,2) Mio. € Aufwandssaldo im Finanzergebnis und -2,2 (-1,6) Mio. € Ertragsteuern schloss die PaulanerTochter mit 5,4 (3,9) Mio. € Halbjahresgewinn im Konzern. Beschäftigt wurden im Schnitt 914 (913) Mitarbeiter.
Heute in der Brau-BörsenBilanz
• ABI
• Carlsberg
• Heineken
• Kulmbacher
• Veltins

Die Konzernbilanz kürzte sich zum 30. Juni 2022 (Ultimo 2021) auf 234 (235) Mio. €. Auf der Vermögensseite stiegen die Buchwerte von Sachanlagen (110 nach 107 Mio. €) etwas weniger stark als das Umlaufvermögen zurückging. Auf der Finanzierungsseite wurden vornehmlich die langfristigen Finanzverbindlichkeiten abgebaut (14 nach 16 Mio. €) bei 75,4 (75,1) Mio. € Eigenkapital (Quote 32,2 nach 31,9 %). Cash investiert haben die Oberfranken im 1. Halbjahr 2022 (2021) brutto 13,8 (9,9) Mio. € und netto 8,9 (8,0) Mio. € (Einzahlungen 2022 insb. aus Abgabe des Güterbahnhofsgeländes Kulmbach), vornehmlich für Kapazitätsausbau in Kulmbach (Produktion und Logis tik) sowie Mehrweggebinde.
Gewinnplus und Mehrinvest im 1. Halbjahr 2022
Netto umgesetzt hat IFRS-Bilanziererin Kulmbacher im 1. Halbjahr 2022 (2021) konzernweit +5,2 % mehr auf 123,9 (117,8) Mio. €. Hinzu kamen +1,7 (+0,5) Mio. € Lageraufbau und 3,8 (2,9) Mio. € sonstige betriebliche Erträge. Der Materialaufwand stieg nur +3,5 % (47,3
Höhere Risiken im 2. Halbjahr
Im Gesamtjahr 2022 hänge die Geschäftsentwicklung aus Sicht August 2022 ab von den Auswirkungen des RusslandUkraine-Konflikts, den starken Rohstoff- und Energiekostensteigerungen und „letztendlich von
der ausreichenden Verfügbarkeit von Gas für die Produktion“, wie es im Zwischenbericht hieß, zudem vom weiteren Pandemieverlauf. Im Falle relevanter Änderungen in der Prognose während des 2. Halbjahrs 2022 werde Kulmbach zeitnah informieren.
Veltins: Rekordausstoß im 1. Halbjahr, 2. Halbjahr unwägbar
Die Brauerei C. & A. Veltins meldete für ihr 1. Halbjahr 2022 (2021) +10,1 % Mehrausstoß auf ein Allzeithoch von 1,71 (1,55/1,50/1,57) Mio. hl Getränken. Von der Dachmarke „Veltins“ seien dabei +12,7 % mehr produziert worden auf 1,26 Mio. hl. Fürs „Helle Pülleken“ wurden +24,9 % auf 124 Thl genannt, während die „Grevensteiner“ -15,2 (nach +0,4) % abgaben (im 1. Halbjahr 2021 lagen sie etwa auf dem aktuellen „Pülleken“-Niveau). „V+“Mixes seien +3,3 (-5,7) % vorangekommen und die „Fassbrause“ +5,6 (+28) %. Für ihre Kanäle nannten die Hochsauerländer 194 Thl im Fass und 77 % vom Fassbiervolumen 2019. Im nationalen Handel habe der Getränkeabsatz hingegen ca. -5 %
abgegeben. Meschede sah sich unverändert stabil und ertragsstark aufgestellt. Trotz unwägbarem 2. Halbjahr 2022 – Veltins stellte an -
22 Brauerei Forum – Oktober 2022 BETRIEBSWIRTSCHAFT
Der Krieg in der Ukraine und die anhaltenden Lieferengpässe, insbesondere im Energiebereich, verlangsamen die wirtschaftliche Erholung von der Corona-Pandemie in Deutschland und Europa in nahezu allen Wirtschaftsbereichen. Zudem sind das Ende der Inflation und deren wirtschaftliche und soziale Folgen noch nicht absehbar.
Aus dem Halbjahresbericht 2022 der Kulmbacher Brauerei AG
gesichts der unsicheren Gasversorgung keine Prognose – plante die Traditionsbrauerei zur Julimitte in absehbarer Zeit keine Preiserhöhung, solange dies wirtschaftlich vertretbar sei. Veltins habe Vorkehrungen getroffen und Tankkapazitäten aufgebaut, um im Falle eingeschränkter Gasversorgung binnen weniger Stunden im Kesselhaus von Gas- auf Heizölbefeuerung umzustellen, und zusätzliche Vorräte bei Gebinden, Paletten und Verbrauchsmaterial angelegt, für die 30 Mio. € Mittel vorgezogen worden seien.
ABI: Mehrabsatz im 2. Quartal 2022 aus Lateinamerika Weltbierprimus Anheuser-Busch InBev hat im 2. Quartal 2022 (2021) seinen Getränkeabsatz +4,9 Mio. hl bzw. +3,4 % auf 149,7 (144,8) Mio. hl ausweiten können. Die Mehrmenge kam komplett aus dem laufenden Geschäft. Der Eigenbierabsatz wurde dabei mit 131,1 (128,6) Mio. hl gemeldet, davon +3,4 Mio. hl bzw. +2,7 % vergleichbar und -0,9 Mio. hl aus einer geänderten Berichtslogik für Bier- und Nicht-Bier-Absätze. Die sonstigen Getränke legten vergleichbar +8,2 % zu. Das GetränkePlus kam aus Südamerika (36,4 nach 33,5 Mio. hl, vergleichbar +8,6 %) und Mittelamerika (37,8 nach 34,9 Mio. hl, vergleichbar +8,2 %): Peru sei im Bereich von 25 % gesprungen, Ekuador etwas über 20 %, Kolumbien im Bereich von 15 %, Brasilien um +10,4 % (dabei Bier +8,5 %) und Mexiko hoch einstellig bei weitgehend stabilem Argentinien. In Brasilien sollte das dort 2021 gestartete „Spaten“ ausgebaut werden. Europa/Nahost/Afrika (22,8 nach 22,9 Mio. hl, vergleichbar -0,3 %) und Asien/Pazifik (25,1 nach 25,2 Mio. hl, vergleichbar -0,4 %) zeigten
sich knapp behauptet: Europa habe klein einstellig mehr verkauft, Südafrika stabil gelegen und China durch die Pandemie -6,5 % abgegeben. Nordamerika tendierte -2,7 % schwächer auf 27,4 (28,1) Mio. hl: Der US-Großhändlerabsatz (STW) tendierte gleichfalls -2,7 %. Ihren Nettoumsatz konnte IFRS-Bilanziererin ABI im 2. Quartal 2022 kräftig ausweiten auf 14,8 (13,5) Mrd. US-$ dank +7,5 % höherem hl-Umsatz. Vergleichbar wurden +1,5 Mrd. US-$ bzw. +11,3 % mehr erlöst, aus Konzernveränderungen kamen -0,1 Mrd. US-$, aus den Wechselkursen -0,2 Mrd. US-$. Südamerika sprang auf 2,6 (1,9) Mrd. US-$ (vergleichbar +0,6 Mrd. US-$ bzw. +30,2 %), gefolgt von Mittelamerika auf 3,6 (3,1) Mrd. US-$ (vergleichbar +0,6 Mrd. US-$ bzw. +18,4 %). Europa/ Nahost/Afrika gewann vergleichbar +8,7 % und Asien/Pazifik +3,7 %, wobei die Wechselkurse diese währungsbereinigten Mehrumsätze weitgehend oder komplett wieder aufzehrten. Und Nordamerika kam vergleichbar +2,7 % voran.
Russland-Ausstieg drückt auch Halbjahresgewinn
Damit hat Leuven im 1. Halbjahr 2022 (2021) 289,1 (280,4) Mio. hl Getränke verkauft (+3,1 %), davon 251,7 (247,6) Mio. hl Eigenbier (+5,9 Mio. hl bzw. +2,4 % vergleichbar, -1,9 Mio. hl aus der geänderten Berichtslogik). (Im 1. Halbjahr 2019 waren es ohne Australien 276,0 Mio. hl, davon 244,1 Mio. hl Eigenbier.) Netto umgesetzt wurden daraus 28,0 (25,8) Mrd. US-$. 1 US-$ wertete im 1. Halbjahr 0,91 € und zum 30. Juni 0,96 €. (Im 1. Halbjahr 2019 lag der Umsatz ohne Australien bei 25,8 Mrd. US-$.) Vergleichbar wurden +2,9 Mrd. US-$ bzw. +11,5 % mehr erlöst, aus Konzernveränderungen kamen -0,2 Mrd. US-$ und aus den Wechselkursen -0,5 Mrd. US-$. Die direkten Umsatzkosten sprangen überproportional +16,6 % (vergleichbar sogar +18,7 %) auf 12,8 (11,0) Mrd. US-$. Der Betriebsgewinn vor Einmaleffekten kam voran auf 7,1 (6,8) Mrd. US-$. Betriebliche Einmaleffekte saldierten sich auf -0,1 (-0,2) Mrd. US-$ Aufwand (davon -47 Mio. US-$ aus dem RusslandAusstieg). Das Finanzergebnis sank auf -3,3 (-2,2) Mrd. US-$ Aufwandssaldo: Es enthält -1,143 Mrd. US-$ Wertberichtigung auf den ABIAnteil an AB InBev Efes infolge des
Leuven-Rückzugs aus Russland. (AB InBev Efes ist als Gemeinschaftsunternehmen nicht im Konzernabsatz und in der Konzern-Ergebnisrechnung oberhalb vom Beteiligungsergebnis enthalten.) Der laufende Nettozinsaufwand wurde mit -1,7 (-1,8) Mrd. US-$ mitgeteilt. Nach konstant -1,2 Mrd. US-$ Ertragsteuern schloss der Konzern mit 2,47 (3,07) Mrd. US-$ Halbjahresgewinn, von dem 1,69 (2,46) Mrd. US-$ den Aktionären der Mutter zuzurechnen waren. Direkt im Eigenkapital gebucht wurden +1,73 (-1,09) Mrd. US-$ Mehrung (Vorjahr: Minderung), überwiegend aus der Bilanzumrechnung von Fremdwährungstöchtern. Die Konzernbilanz kürzte sich zum 30. Juni 2022 (Ultimo 2021) auf 212 (218) Mrd. US-$. Der Rückgang betraf beim Vermögen vor allem Kasse sowie AB InBev Efes-Wertansatz, bei der Finanzierung vor allem die langfristigen verzinslichen Verbindlichkeiten sowie Verbindlichkeiten aus Lieferungen und Leistungen bei 82,8 (79,3) Mrd. US-$ Eigenkapital. Der ABI-Betriebsinvest lag im 1. Halbjahr 2022 (2021) netto cash bei 1,9 (2,1) Mrd. US-$. Für ihr Gesamtjahr 2022 erwartete ABI Ende Juli unverändert 4-8 % EBITDAZuwachs bei noch stärkerem Umsatzplus und netto 4,5-5 Mrd. US-$ Invest.
Heineken freut sich über Asien/ Pazifik und Europa-Gastronomie Der Konzern um die Heineken N.V. hat seinen Getränkeabsatz im 2. Quartal 2022 (2021) auf 79,0 (67,6) Mio. hl ausgeweitet. Das laufende Geschäft legte +6,3 Mio. hl bzw. +9,3 % zu, die Vollkonsolidierung der indischen UBL brachte weitere +5,1 Mio. hl. Die Bierverkäufe stiegen dabei auf 70,4 (59,6) Mio. hl (+5,8 Mio. hl bzw. +9,7 % vergleichbar, +5,1 Mio. hl von UBL). Sonstige Getränkeabsätze stellten sich Amerika halber -0,2 Mio. hl bzw. -3,3 % auf 6,3 (6,6) Mio. hl. Und Handelsware stieg dank Europa-Gastronomie auf 2,2 (1,5) Mio. hl. Der Gruppenbierabsatz, er enthält zusätzlich konstant 2,2 Mio. hl Lizenzbier bei Dritten und die anteiligen Absätze von Beteiligungen, wurde mit 79,8 (71,1) Mio. hl genannt. Zurück zum Konzern-Getränkeabsatz: Asien/Pazifik sprang dort auf 13,3 (6,1) Mio. hl (vergleichbar +2,1 Mio. hl bzw. +34 %, +5,1 Mio. hl von UBL). Europa legte +8,1 % zu auf 29,2 (27,0)
23 Brauerei Forum – Oktober 2022
Mio. hl. Amerika gewann +7,8 % auf 23,7 (22,0) Mio. hl. Afrika/Nahost/Osteuropa kam voran auf 12,8 (12,5) Mio. hl (+0,3 Mio. hl bzw. +2,5 % vergleichbar, -0,1 Mio. hl aus Konzernveränderungen). Die Marke „Heineken“ verkaufte 14,0 Mio. hl (+14,6 %). Netto umgesetzt hat IFRS-Bilanziererin Heineken daraus im 2. Quartal konzernweit 7,73 (5,66) Mrd. €. Im laufenden Geschäft sprangen die Erlöse +1,35 Mrd. € bzw. +23,9 %, aus Konzernveränderungen kamen +0,27 Mrd. € (davon +0,29 Mrd. € von UBL) und aus den Wechselkursen +0,45 Mrd. €.
1. Halbjahr 2022: Gewinnplus trotz Rohstoff-Inflation
Im 1. Halbjahr 2022 (2021) hat Amsterdam im Konzern 142,2 (124,1) Mio. hl Getränke verkauft (+9,5 Mio. hl bzw. +7,7 % vergleichbar, +8,6 Mio. hl aus Konzernveränderungen, davon +8,7 Mio. hl von UBL). (Im 1. Halbjahr 2019 waren es 133,1 Mio. hl.) Dabei standen Bier für 126,9 (109,9) Mio. hl, sonstige Getränke für 11,5 (12,1) Mio. hl und Handelsware für 3,8 (2,1) Mio. hl. Hinter +7,9 % vergleichbarem Europa-Bierplus (bei klein einstelligem Rückgang in Polen) stand ein Sprung im hohen 70-%-Bereich in der Gastronomie, anteilig kompensiert durch ein mittel einstelliges Minus im Handel. Die Gastronomie liege in Europa noch im hoch einstelligen Prozentbereich unter 2019, der Handel indes hoch einstellig darüber. Der Gruppenbierabsatz wurde incl. 4,8 (4,4) Mio. hl Lizenzbier bei Dritten mit 146,1 (132,1) Mio. hl angegeben. Die Marke „Heineken“ verkaufte 25,9 Mio. hl (+13,8 %). „Amstel“ sprang im hohen 20-%-Bereich, „Tiger“ im Bereich von 15 %. „Sol“ kam klein einstellig voran, ebenso der Konzernabsatz bei Alkoholarm und -frei. Erlöst hat der Amsterdamer Konzern daraus im 1. Halbjahr 2022 (2021) netto 13,49 (10,01) Mrd. €, davon +2,42 Mrd. € bzw. +24,3 % vergleichbar (hl-Umsatz +15,6 %), +0,45 Mrd. € aus Konzernveränderungen und +0,64 Mrd. € aus Wech -
selkursen. (2019 waren es 11,44 Mrd. €.) Der Aufwand ohne Personal und Abschreibungen sprang +44 % auf 8,6 (6,0) Mrd. €: Allein die vergleichbaren Inputkosten sprangen durch Inflation und Premiumtrend auf hl-Basis um etwas unter 20 %. Der Betriebsgewinn kam voran auf 2,07 (1,72) Mrd. €. Nach leicht verbessertem Finanzergebnis und höheren Ertragsteuern schloss Amsterdam im Konzern mit 1,46 (1,17) Mrd. € Halbjahresgewinn (2019: 1,04 Mrd. €), von dem 1,27 (1,03) Mrd. € den N.V.-Aktionären zuzurechnen waren. Direkt im Eigenkapital gebucht wurden +1,20 (+0,55) Mrd. € Mehrung, weitgehend aus der Bilanzumrechnung von Fremdwährungstöchtern. Die Konzernbilanz längte sich zum 30. Juni 2022 (Ultimo 2021) auf 52,3 (48,9) Mrd. € bei 21,6 nach 19,7 Mrd. € Eigenkapital. Und der Betriebsinvest stieg im 1. Halbjahr 2022 (2021) netto cash auf 1,05 (0,93) Mrd. €. Amsterdam erweitere Kapazitäten in Brasilien, Nigeria, Vietnam, Mexiko, Italien, Malaysia und Ruanda. Bei Ankündigung ihres Rückzugs aus Russland hatte Heineken die damit verbundenen Wertberichtigungen und weiteren nicht zahlungswirksamen Belastungen auf ca. 0,4 Mrd. € geschätzt. Der Halbjahresabschluss 2022, der das Russland-Geschäft per 30. Juni als zum Verkauf stehend ausweist, enthält indes auf Basis neuerer Annahmen keine Wertberichtigungen: Amsterdam gehe inzwischen davon aus, dass mit der fürs 2. Halbjahr 2022 erwarteten Abgabe kein Buchverlust verbunden sein werde. Für ihr Gesamtjahr 2022 bestätigte Heineken am 1. August ihren Ausblick auf eine gegenüber 2021 stabile oder sukzessive leicht verbesserte Betriebsmarge (vor Einmaleffekten und Markenabschreibungen). Ab 2023 prognostiziert Amsterdam keine Margen mehr, sondern absolute Zahlen: Ohne wesentliche volkswirtschaftliche oder politische Überraschungen wolle Heineken 2023 beim vergleichbaren Betriebsgewinn (vor Einmaleffekten und Markenabschreibungen) im mittel bis hoch einstelligen Prozentbereich wachsen. Wachsam beobachte man möglichen Kaufkraftdruck auf die Konsumentennachfrage und erheblichen Inflationsdruck auf die eigene Kostenbasis.
Carlsberg freut sich im 2. Quartal 2022 über Asien
Der Konzern um die Carlsberg A/S hat sein Russlandgeschäft bereits zum 1. Januar 2022 als zum Verkauf stehend ausgewiesen und die Vergleichszahlen 2021 über ein Restatement angepasst. Auf dieser um Russland verkürzten Basis stieg der Kopenhagen-Konzernabsatz im 2. Quartal 2022 (2021) bei Bier auf 29,9 (28,1) Mio. hl: Asien sprang auf 12,2 (10,8) Mio. hl, Westeuropa kam voran auf 9,1 (8,9) Mio. hl und Mittelund Osteuropa auf 8,6 (8,4) Mio. hl. Sonstige Getränke sprangen auf 6,4 (5,4) Mio. hl dank Westeuropa (3,9 nach 3,2 Mio. hl) sowie Asien. Stiegen die Getränkeverkäufe im Konzern so um über +8 % auf ca. 36,3 (ca. 33,5) Mio. hl, sprangen die Nettoumsätze um +21,6 % auf 20,5 (16,9) Mrd. DKK. (1 € galt am 30. Juni 2022 7,44 DKK.)
1. Halbjahr 2022: Russland-Ausstieg drückt auf Erfolgsrechnung Im 1. Halbjahr 2022 (gegenüber angepasstem 2021) hat der Konzern damit +6,4 % mehr Bier verkauft auf 52,6 (49,4) Mio. hl (+7 %punkte aus dem laufenden Geschäft, -0,6 %punkte aus Nepal-Entkonsolidierung). Westeuropa legte +6,5 % zu auf 15,3 (14,3) Mio. hl: Die Schweiz sei kräftig gewachsen, Skandinavien habe gutes Mengenplus gezeigt, die Gastronomieerholung in Großbritannien sowie Frankreich jeweils mehr Absatz gebracht als im Handel verlorenging, und Polen dank gutem 2. Quartal stabil gelegen. Asien sprang auf 23,4 (21,2) Mio. hl (+12,2 %punkte vergleichbar, -1,4 %punkte Nepal): In einem mittel einstellig rückläufigen ChinaBiermarkt habe Kopenhagen Anteile gewonnen, Vietnam sei im Bereich von knapp 20 % gesprungen, Laos stark gewachsen und Indien über dem Niveau von 2019 herausgekommen. Osteuropa zeigte sich knapp behauptet bei 13,9 Mio. hl (-0,2 %), durch den kriegsbedingten Einbruch in der Ukraine (-27 % beim Gesamtabsatz). Carlsbergs drei Ukrai ne-Brauereien konnten bis Ende Juni wieder in Betrieb genommen werden. Italien, Serbien und Kroatien wuchsen zweistellig. Bei den Marken sprang „Carlsberg“ +20 % und „Tuborg“ +14 %. Alkoholfreie Braugetränke gaben -3 % ab (ohne Ukraine +4 %). Sonstige Getränke sprangen konzernweit

24 Brauerei Forum – Oktober 2022 BETRIEBSWIRTSCHAFT
+18 % auf 11,6 (9,8) Mio. hl. Der Getränkeabsatz insgesamt legte vergleichbar +8,9 % zu und schloss +11 % über 2019 (ohne Russland). Der Gastronomieabsatz habe dabei gruppenweit wieder sein Niveau von 2019 erreicht.
Der Nettoumsatz von IFRS-Bilanziererin Carlsberg sprang im 1. Halbjahr 2022 (gegenüber angepasstem 2021) +23,6 % auf 35,4 (28,7) Mrd. DKK (+21 % über 2019 ohne Russland). Das laufende Geschäft stand für +20,7 %punkte (hlUmsatz +11 %), Nepal für -0,9 %punkte und die Währungsumrechnung für +3,8 %punkte. Die direkten Umsatzkosten sprangen +27,6 % auf 19,0 (14,9) Mrd. DKK. Das Betriebsergebnis stieg auf 5,58 (4,57) Mrd. DKK. Es enthielt -0,87 (-0,17) Mrd. DKK Aufwandssaldo aus Einmaleffekten (2022 mit -0,7 Mrd. DKK Goodwill-Abschreibung auf Mittel- und Osteuropa und -0,14 Mrd. DKK Wertberichtigungen in der Ukraine). Nach niedrigerem Finanzergebnis und konstanten Ertragsteuern zeigte Kopenhagen 3,95 (3,20) Mrd. DKK Gewinn aus fortgeführtem Geschäft. Das zum Verkauf stehende Russlandgeschäft belastete mit -8,62 Mrd. DKK Nettoverlust (aktuell -9,56 Mrd. DKK Wertberichtigung, vgl. BF Juni/Juli 2022, S. 28, und +0,94 Mrd. DKK Halbjahresgewinn). Damit schloss Kopenhagen mit -4,66 (+3,51) Mrd. DKK Halbjahresverlust (Vorjahr: Gewinn). Direkt im Eigenkapital gebucht wurden -0,36 (+1,87) Mrd. DKK Minderung (Vorjahr: Mehrung), 2022 vornehmlich im Zusammenhang mit Sicherungsgeschäften. Die Bilanz längte sich zum 30. Juni 2022 (Ultimo 2021) auf 128 (126) Mrd. DKK bei 38 (49) Mrd. DKK Eigenkapital (Rückgang aus Halbjahresverlust, Dividendenzahlung sowie Aktienrückkauf). Der Betriebsinvest lag im 1. Halbjahr 2022 netto cash bei 1,38 (1,55) Mrd. DKK. Carlsberg hob im August die Prognose für ihr fortgeführtes Geschäft im Gesamtjahr 2022 an und erwartete beim vergleichbaren Betriebsgewinn nun einen Zuwachs im hoch einstelligen Prozentbereich. Auch Kopenhagen sieht im Anstieg ihrer Inputkosten eine besondere Herausforderung für die kommenden Quartale und sorgt in Europa vor für mögliche Probleme bei der Erdgasversorgung. S.W.
Konzernabschlüsse im Überblick
1. Halbjahr 2022 (30.06.) AB InBev Heineken Carlsberg Molson Coors
Konzernabschluss nach IFRS IFRS IFRS US-GAAP
Abschlusswährung US-$ € DKK US-$ Halbjahresdurchschnitt Abschlusswährung/EUR 1,09 – 7,44 1,09 Mio. €
Umsatz netto 25 603 13 485 4765 4692
Betriebsergebnis vor Einmaleffekten 6491 2.155 866 335 Betriebsergebnis-Marge vor Einmaleffekten (%) 25,4 16,0 18,2 7,1 Einmaleffekte -96 -85 -116 -26 Finanzergebnis* -2072 -148 -68 -100
Beteiligungsergebnis -926 80 (64 im Betriebsergebnis) –Sonstiges Ergebnis – – – -1 Ertragsteuern -1136 -547 -150 -40 Ergebnis aus nicht fortgeführtem Geschäft – – -1158 –Konzernhalbjahresüberschuss 2260 1455 -627 169 Umsatzrendite (%) incl. Einmaleffekte 8,8 10,8 -13,2 3,6
Sonstige erfolgsneutrale Eigenkapitalveränderung 1584 1198 -48 -59
Cashflow aus betrieblicher Tätigkeit 1993 2169 1126 609
Cashflow aus Investitionstätigkeit -1751 -1091 -146 -338
davon Betriebsinvest netto (MC: incl. Verkauf sonst. Anlagen) -1771 -1047 -185 -341 Cashflow aus Finanzierungstätigkeit -4926 -1516 -302 -429 Halbjahresultimo Abschlusswährung/€ 1,04 – 7,44 1,04
Mio. € Bilanzsumme 204 484 52 349 17 242 26 367 Immaterielle Vermögenswerte in den Aktiva 150 008 21 357 6754 18 429 Liquidität in den Aktiva 6765 2889 1786 426 Zum Verkauf stehende Aktiva 29 550 2221 –Eigenkapital in den Passiva 79 667 21 556 5068 13 096 Eigenkapitalquote (%) 39,0 41,2 29,4 49,7
Mitarbeiter
Allgemeine Angabe ca. 169 000 >85 000 –(ca. 16 300 Ultimo 2021)
Mio. hl
Konsolidierter Getränkeabsatz 289,1 142,2 64,2 –Konsolidierter Bierabsatz (ABI: Eigenbier; MC: financial volume inkl. sonst. Getränke) 251,7 126,9 52,6 39,8 Gruppenbierabsatz (unkonsolidiert) – 146,1 – –
*ABI-Finanzergebnis mit -1537 Mio. € laufendem Nettozinsaufwand. Carlsberg-Cashflow ohne Anteile aus nicht fortgeführtem Geschäft
25
Forum – Oktober 2022
Brauerei
Ivan Zonev und Hristo Hristov (Sieger aus Bulgarien), Christian Kröll (Zweitplatzierter aus Deutschland), Federico Vauthier (Drittplatzierter aus Italien), Dr. Axel Göhler (Geschäftsführer Bestmalz AG), Maximilian Maier und Johann Schnierdas (Design-Preis für die beste Gesamtpräsentation), Jan Mordhorst (Design-Preis für das beste Flaschenlabel) und Mareike Hasenbeck (Moderatorin der Siegerehrung)
Die Sieger kommen aus Bulgarien, Deutschland und Italien
Aus Sudkesseln von Hobbybrauern stammen die Altbiere, die bei der BestBrewChallenge 2022 aus 155 eingereichten Bieren zu den Besten gekürt wurden. Den Sieg tragen Ivan Zonev und Hristo Hristov aus Bulgarien davon. Zweitplatzierter ist Christian Kröll aus Deutschland. Auf den dritten Platz kommt Federico Vauthier aus Italien. Dieser Brauwettbewerb wird jährlich von Bestmalz ausgeschrieben und durchgeführt.

(F.) In einem Blind Tasting wurde das Siegerbier von der Fachjury als „typisches Alt mit ausgewogener Bittere und sanfter Kirschnote“ beurteilt. Zudem überzeugte es durch angenehme Röst- und klassische deutsche Hopfennoten. Auch eine schokoladige Note konnten die Sommeliers deutlich herausschmecken, gemäß der Wettbewerbsvorgabe, BEST Chocolate Malz zu verwenden.
Das Bier des Zweitsiegers wurde in Nordrhein-Westfalen gebraut, der Heimat des klassischen Altbiers. Das „Büd Alt“ punktete mit nussigen Malznoten, einer schmeichelnden Bittere und „einer hohen Trinkfreude“, sagte Biersommelière Mareike Hasenbeck. Der dritte Platz ging an Federico Vauthier aus Italien. Ihm gelang es, in seinem „Garage Beer Lab“ Noten von Karamell, Rosinen und Toffee ins Bier zu bringen.
Alle Altbier-Kreationen, die die Endrunde erreicht hatten, lagen in Bezug auf Farbe, Schaum, Geruch, Bittere, Geschmack, CO2-Sättigung sowie Drinkability sehr nah am klassischen Altbier.
Insgesamt wurden 155 Altbiere aus aller Welt zu dem Brau-Wettbewerb eingeschickt und von der Fachjury verkostet. „Ein neuer Rekordwert“, freut sich Bestmalz-Chef Dr. Axel Göhler, der den Wettbewerb 2015 ins Leben gerufen hat.
„Die internationale Beteiligung kann sich sehen lassen.“ Einzelne Biere kamen aus Dänemark, Norwegen, Lettland, Tschechien, Kanada, den Niederlanden und der Schweiz. Aus Bulgarien wurden vier Biere in PET-Flaschen eingeschickt, darun -
ter das Siegerbier. Die weitesten Wege legten Einsendungen aus den USA und Australien zurück. Die meisten Biere kamen aus Deutschland (73), Litauen (36) und Italien (14). Die Siegerehrung fand am Dienstag, den 13. September 2022, am Bestmalz-Messestand auf der internationalen Getränkemesse drinktec in München statt. Dort wurde auch das Siegerbier ausgeschenkt, das für diesen Zweck im Neckarsulmer Brauhaus nachgebraut wurde. Erstmals wurden im Rahmen der BestBrewChallenge besonders krea tive Verpackungen und Flaschen-Label prämiert. Für die beste Gesamtpräsentation bezogen auf die Kombination aus Verpackung und Flaschen-Label wurde Maximilian Maier ausgezeichnet, der sein Bier „Alte Gärlinde“ in einer mit Heu
gepolsterten Holzkiste weich bettete. Das Label zeigt eine charmante ältere Dame. Begleitet wird die Einsendung durch hölzerne Bierdeckel und Schildchen mit Lasergravur. Ein Flaschen-Label à la Adventskalender mit aufklappbaren Türchen hatte Jan Mordhorst für seine BierKreation „ALTe Liebe“ entworfen. Besonderen Spaß beim Auspacken hatte das Bestmalz-Team bei der Einsendung der Lielukos-FamilyBrewery aus Litauen: Passend zum Biernamen „Treasure“ (engl. für Schatz) bestand die Verpackung aus einer hölzernen Schatzkiste. Im Innenraum waren die Bierflaschen von gerösteten Malzkörnern und goldfarbenen Münzen umgeben. Die Ausschreibung zur nächsten Challenge erfolgt voraussichtlich im Januar 2023.
26 Brauerei Forum – Oktober 2022 MARKT & MARKEN BESTBREWCHALLENGE 2022
Foto: Bestmalz/Katharina C. Müller
ABInBev startet digitalen B2B-Marktplatz

„BEES“ in Deutschland
Erst zwei Jahre jung, schon einer der zehn größten Online-Marktplätze der Welt – und ab Frühjahr 2023 in Deutschland verfügbar: Mitte September hat Anheuser-Busch InBev in München die Einführung von BEES auf dem deutschen Markt verkündet. Mit der ersten eigenen digitalen B2B-Plattform und mehr als 2,9 Millionen Nutzern im Monat, setzt der weltweit größte Brauereikonzern neue Maßstäbe im E-Commerce.
(F.) www.bees.com ermöglicht rund um die Uhr erdumspannenden Online-Handel. Kunden können dort flexibel Produkte suchen, bestellen, Lieferungen veranlassen, Prämien sammeln und Rechnungen verwalten. Doch der Erfolg der Plattform hat weitere wichtige Gründe. So erhalten Nutzer etwa digitalen Zugang zu einem riesigen globalen Netzwerk, zu wertvollem Branchenund Marketing-Wissen.
Mit der integrierten Bestell- und Lieferplattform unterstützt der Brauereikonzern seine Kunden und Partner weltweit und bringt auch Schwung ins Geschäft kleiner und mittelgroßer sowie lokal ansässiger Unternehmen. Zur Angebotspalette von BEES gehören schon heute Produkte von Drittunternehmen, die ebenfalls von der hohen Reichweite profitieren.
Weltweite Entscheidung
Nachdem der Online-Markplatz im Juli im britischen Markt eingeführt worden ist, geht BEES nun in Deutschland an den Start. „Zunächst wurde die Plattform in Lateinamerika, den USA, Südafrika und China eingeführt. Das gab uns die Gelegenheit, ausgiebig zu testen und zu verbessern“, so Nick Caton, Chief BEES Officer, Anheuser-Busch InBev. „Nun ist es so weit, dass wir einen entscheidenden Schritt vorwärtsgehen. Wir bringen BEES nach Europa. Diese Expansion wird unserem rasch wachsenden digitalen Marktplatz noch einmal wichtigen Auftrieb geben.“
Innerhalb Europas ist der Wirtschaftsstandort Deutschland für Anheuser-Busch InBev von zentraler Bedeutung. Mit den ersten zwei Pilotkunden startete im Au -
gust 2022 die Implementierungsphase. Während der kommenden zwei bis drei Jahre wird BEES im deutschen Markt weiter ausgebaut. Dafür etabliert der Konzern derzeit strategische Allianzen mit großen Partnern im deutschen Fachgroßhandel.
BEES vernetzt alle Beteiligten entlang der Lieferkette miteinander. Zu den Kunden zählen insbesondere Gastronomen und Leiter von Getränkeabholmärkten. Sie profitieren gleich mehrfach. Sie können jederzeit bequem Produkte bestellen, leichter mit Verkäufern interagieren und attraktive Prämien sammeln. Preise und Werbeangebote sind übersichtlich und transparent gestaltet. Zudem erhält diese Zielgruppe wichtige Informationen dazu, wie sie durch kreative Promotions und Marketingmaßnahmen ihren Absatz steigern können. Alle teilnehmenden Kunden und Handelspartner von AnheuserBusch InBev nutzen BEES auf freiwilliger Basis. Eines der Motive, warum sich so viele von ihnen für den Online-Marktplatz entscheiden: Die Plattform lernt mithilfe künstlicher Intelligenz dazu, bietet etwa algorithmische Vertriebsunterstützung und ein maßgeschneidertes Kauferlebnis.
Anspruchsvolle Technologie
„BEES ist nicht ohne Grund ein Senkrechtstarter“, erklärt Michel Pepa, Country Director Germany, Anheuser-Busch InBev. „Wir machen das Leben unserer Kunden leichter und steigern nachhaltig die Profitabilität unserer Partner. Nach drei Jahren intensiver Planung und einer Investition von rund 1 Mrd. US-$ fiel der Startschuss für
unseren Online-Marktplatz im Jahr 2020 in der Dominikanischen Republik. Heute, nur zwei Jahre nach dem Pilotprojekt, zählt sie zu den Top Ten der E-Commerce-Plattformen, generiert in 20 Ländern weltweit fast 1,8 Mio. Bestellungen pro Woche sowie einen Bruttowarenwert von über 30 Mrd. US-$ pro Jahr. Wir erzielen bereits 53 % unseres Umsatzes auf digitalem Weg. Die Technologie ist das Herzstück unserer auf zehn Jahre ausgelegten Wachstumsstrategie – und BEES ein elementarer Baustein dieser Strategie.“
Algorithmusbasierte Kaufempfehlungen der Plattform bescheren Anheuser-Busch InBev und teilnehmenden Fachgroßhändlern bei 80 % der Nutzer Einkäufe, die durchschnittlich 3 % größer ausfallen als Bestellungen, die via Katalog erfolgen. Zugleich gelingt es dem Brauereikonzern mit seinen weltweit 6 Mio. Kunden und 2 Mrd. Konsumenten, Präsenz und Wert der weltweit erfolgreichen Produktmarken durch BEES weiter zu steigern. Auch für Endkunden hat der Marktplatz entscheidende Vorzüge: Sie können auf eine weitaus größere Produktpalette bei ihrem Händler vor Ort zugreifen und finden dort etwa internationale Marken im Regal. Entsprechend schafft die Plattform eine Win-Win-Situation für alle Beteiligten, so ABInBev.
27 Brauerei Forum – Oktober 2022
E-COMMERCE
Die Gewinner des diesjährigen European Beer Stars nahmen ihren Award auf der drinktec in München in Empfang

NACHRICHTEN
Becker's zeigt sich verjüngt
Die Marke Becker’s aus St. Ingbert im Saarland ist weltweit in über 25 Ländern bekannt und steht seit 1877 für Braukunst. Die Karlsberg Brauerei stärkt das traditionsreiche Premium-Pils jetzt mit einem neuen Markenauftritt, der an das Design aus früheren Jahren erinnert.
(F.) Becker’s Pils zeigt sich ab sofort in einem neuen Look. Mit einem Designrelaunch macht die Karlsberg Brauerei das Premium-Pils fit für das Hier und Heute.

Neu, aber nicht unbekannt, sind die Farbigkeit und die Form des Etiketts. Das traditionelle Schwarz und Silber weichen einem frischen Weiß-Gelb, den traditionellen Becker’s-Farben, im rechteckigen Format. Was bleibt: Der charakteristische Becker-Turm im Logo, der einst das Markenzeichen der Stadt St. Ingbert war. Dieser ist ab sofort auch auf dem Kronkorken zu finden. Auch der bekannte Slogan „Am liebsten Becker's Pils“ kommt wieder zum Einsatz. „Becker’s Pils ist und bleibt in unserer Heimat eine lokale Größe. Aber auch darüber hinaus hat das Premium-
Pils seine Anhänger. Wir sehen weiterhin einen starken Trend zu dieser Biermarke mit Tradition, dem wir mit dem Designrelaunch Rechnung tragen“, sagt Andreas Oster, Marketingleiter der Karlsberg Brauerei.
Ab sofort im Handel
Becker’s Pils zeichnet sich durch seinen malzigen, leicht würzigen Geschmack mit langem Abgang bei einem Alkoholgehalt von 4,9 Vol.-% aus. Das Pils im Retro-Gewand ist in der 0,33-Liter-Steini-Flasche im Handel sowie als Fassbier in der Gastro erhältlich.
219 Biere beim European Beer Star ausgezeichnet
Beim European Beer Star 2022 wetteiferten 2168 Biere aus 40 Ländern in 73 Kategorien um die begehrten Awards. Dazu gehören international bekannte Biertypen wie Pilsner, Weißbier oder India Pale Ale, aber auch Spezialitäten wie holzfassgelagerte Stark -
biere, Belgisches Dubbel oder Sauerbiere.
(F.) Eine 130-köpfige internationale Fachjury hat Anfang August die eingereichten Biere in einer zweitägigen Blindverkostung bewertet. Stefan Stang, Hauptgeschäftsführer des Verbands Private Brauereien Bayern e.V., zeigt sich äußerst zufrieden mit der diesjährigen Ausgabe des European Beer Stars: „Wir danken allen, die zum Erfolg unseres 19. European Beer Stars beigetragen haben, und gratulieren allen Brauereien zu ihrem großen Erfolg.“
Die 219 Awards des diesjährigen Bierwettbewerbs gehen in 21 Länder rund um den Globus. Mit 82 Awards, davon 32 Gold, 27 Silber und 23 Bronze, führen die deutschen Brauereien den Medaillenspiegel an. Auf Platz zwei landete Italien mit 35 Medaillen (10 Gold, 9 Silber, 16 Bronze), gefolgt von den US-amerikanischen Brauereien, die 25 der begehrten Awards (8 Gold, 8 Silber, 9 Bronze) über den „großen Teich“ holten.
Mit drei Gold-, zwei Silber- und einem Bronze-Award war Birra Perugia aus der italienischen Provinz Umbrien die erfolgreichste Brauerei des diesjährigen Wettbewerbs. Doch auch für die oberbayerische Brauerei Camba Bavaria (2 Gold, 3 Silber, 1 Bronze) und die Stieglbrauerei aus dem österreichischen Salzburg (1 Gold, 2 Silber, 3 Bronze) regnete es Medaillen. Ausgezeichnet wurden die Gewinnerbiere während der drinktec im September in München.
28 Brauerei Forum – Oktober 2022 MARKT & MARKEN
European Beer Star 2022
Foto: Private Brauereien Bayern
Wulle macht Werbung mit Wulle
Keine Werbung, bitte: Da eine professionelle Marketingkampagne nicht zur Marke WULLE passen würde, gründet die Brauerei kurzerhand eine eigene Kreativagentur, bestehend aus Wulle-Konsumenten und -Konsumetinnen.
(F.) Bierwerbung nervt, professionelle zumindest – so die Meinung der Macher der Wulle-Biere. Deshalb möchte Wulle diese auch vermeiden und hat, in Zusammenarbeit mit der Stuttgarter Kreativagentur Jung von Matt Neckar eine eigene Agentur gegründet: Jung von Matt Plopp. Das dort zukünftig verantwortliche Kreativteam jedoch wird nicht mit professionellen Werbern besetzt – sondern ausschließlich mit Stuttgarter WulleKonsumenten, die von nun an kreative Ideen für die in der Region fest verwurzelte Biermarke entwickeln. Und diese Ideen sind alles – nur eben nicht professionell.
Zusammen kreativ Bisher hat Wulle nie Werbung gemacht, sondern sich viel mehr durch Präsenz in der süddeutschen Kneipenlandschaft sowie auf ausgewählten Events bei einer jungen Zielgruppe zur absoluten Kultmarke entwickelt. Diesen Status will die Tochtermarke der Familienbrauerei Dinkelacker nun auf dem Feld der Werbung weiter ausbauen –sich dabei aber treu bleiben und ihren eigenen Weg gehen: Ohne Hochglanz-Fotos und aufwendig inszenierte LifestyleBildwelten.
Das charakteristische „Plopp“, das beim Öffnen der Bügelflaschen entsteht, in denen Wulle vertrieben wird, ist nicht nur Namensgeber der neu gegründeten Agentur, sondern dort auch regelmäßig zu hören. Denn die auf einem Straßencasting mithilfe von Freibier angeworbenen
Mitarbeiter sollen in einem eigens bei der Agentur eingerichteten Büro das Gefühl bekommen, sich eher auf einer feuchtfröhlichen Party zu befinden als in einer Werbeagentur. So soll das Aufkommen jeglicher
steht, wenn Menschen zusammenkommen und eine gute Zeit haben. Stefan Seipel, Leiter Marketing bei der Familienbrauerei Dinkelacker: „Wulle hat nicht nur Kunden. Wulle hat echte Fans. Und die wissen selbst am besten, was ihnen unser Bier bedeutet und wie man das in kreative Ideen umwandelt. Dass etwas so Echtes von routinierten Werbeexperten geschaffen wird, ist nahezu unmöglich.“

Christian Dinkelacker, Geschäftsführer Familienbrauerei Dinkelacker ist überzeugt: „Für unsere Marke galt immer: Sie macht die Dinge anders. Und so passt ein verrücktes Vorhaben wie dieses genau ins Konzept. Denn eines steht fest: Bierwerbung wie diese gab es noch nie.“
Professionalität verhindert werden. Dass dieses Vorgehen Erfolg hat, zeigen die radikal andersartigen Plakatmotive, die dabei entstanden sind: Ein ausgeklügeltes Brandingkonzept, smarte Slogans und professionelle Layouts sucht man hier vergebens. Stattdessen sind die Motive ein Beleg für die kreative und verrückte Energie, die ent-
Für die kreative Arbeit der Wulle-Agentur gab es nur eine Regel: „Was sich ausgedacht wird, wird auch umgesetzt.“ Und diese wurde ernst genommen. Das belegen die aufmerksamkeitsstarken Plakatierungen in Stuttgart – inklusive der größten Werbefläche der Stadt: dem Rhenus Tower an der B10. Die Mitarbeiter von Jung von Matt Plopp werden selbst ebenfalls Teil der Kampagne: Denn deren Agentur-Tätigkeit wurde filmisch begleitet, um als Content auf den Wulle-SocialMedia-Kanälen gestreut zu werden. Dennoch ist der Agentur- und Kreativalltag bei Plopp nicht nur lustiger Content, sondern ganz nebenbei der Beweis, dass die ungewöhnlichen Motive und Ideen der Amateur-Kreativen tatsächlich auf die Straße gebracht werden.
29 Brauerei Forum – Oktober 2022
Dinkelacker
Bericht von der Jahreshauptversammlung
Am 2. September 2022 trafen sich 28 wahlberechtigte Mitglieder der Landesgruppe Berlin-Brandenburg des Deutschen Braumeister- und Malzmeister-Bundes (DBMB) sowie sechs Gäste zur Jahreshauptversammlung in der Braumanufaktur Werder. Die Tagesordnung sah unter anderem die Neuwahl des Landesgruppenvorstandes vor.

Der Landesgruppen-Vorsitzende Jens Kemmel begrüßte alle Anwesenden, insbesondere die Ehrenmitglieder Dr. Hans-Jürgen Manger und Jörg Kirchhoff. Kemmel richtete seinen Dank an die Eigentümer der Braumanufaktur, Jörg Kirchhoff und Thomas Köhler, für die Ausrichtung der Veranstaltung. Nach dem Verlesen der Tagesordnung würdigte Kemmel den 85. Geburtstag von Bernhard Kahlmeyer sowie den 80. Geburtstag von Jürgen Kloß. Schriftführer Jürgen Richter trug den Bericht der Landesgruppe für das Jahr 2021 vor. Es fanden zwei Mitgliederversammlungen,

ein Sommerausflug und zwei Online-Vorstandssitzungen statt. Einige statistische Angaben zur Landesgruppe rundeten den Bericht ab.
Den Bericht zur Kassenlage hielt stellvertretend für Schatzmeister Sjörn Pahl der 1. stellvertretende Vorsitzende Norbert Heyer. Peik Schauermann in seiner Funktion als Kassenprüfer berichtete, dass die durchgeführte Kassenprüfung keinerlei Einwände und Unregelmäßigkeiten ergab. Beiratsmitglied Dr. Josef Fontaine würdigte die in den vergangenen zwei Jahren geleistete Arbeit des Landesgruppenvorstands und be -
antragte die Entlastung, die einstimmig erfolgte.
Anschließend übernahm der Wahlausschuss unter Leitung von Kirchhoff die Versammlungsleitung. Die Wahl des neuen Landesgruppenvorstands fand in Einzelwahl statt. Die bisherigen Vorstandsmitglieder kandidierten wieder. Gegenkandidaten gab es nicht. Und so setzt sich der neue Vorstand, der einstimmig gewählt wurde, zusammen: Vorsitzender der Landesgruppe: Jens Kemmel (Berliner-KindlSchultheiss-Brauerei)
1. stellvertretender Vorsitzender: Norbert Heyer (VLB Berlin)
2. stellvertretender Vorsitzender: Jens Krtschmarsch (BerlinerKindl-Schultheiss-Brauerei)
Schriftführer: Jürgen Richter (Frankfurter Brauhaus)
Schatzmeister: Sjörn Pahl (Berliner-Kindl-Schultheiss-Brauerei)
Im Anschluss an die Vorstandswahl wurden Peik Schauermann, Katrin Pankoke und Marco Krapf (Stellvertreter) einstimmig als Kassenprüfer gewählt. 27 Stimmen fielen auf Dr. Josef Fontaine und Garlich von Essen in der Beiratsmitglieder-Wahl. Kemmel bedankte sich beim Vorstand für die gute Zusammenarbeit in den vergangenen zwei Jahren. Mit einem Dank von Kemmel für das durch die Mitglieder entgegengebrachte Vertrauen für die Wahl des neuen Vorstands und für die Unterstützung der Landesgruppe durch die Fördermitglieder schloss der offizielle Teil der Jahreshauptversammlung.
Nächster Termin der Landesgruppe: Mitgliederversammlung am 25. November 2022 an der VLB Berlin.
Jürgen Richter
30 Brauerei Forum – Oktober 2022 INSTITUTIONEN & VERBÄNDE
Deutscher Braumeister- und Malzmeister-Bund e.V. – Landesgruppe Berlin-Brandenburg
Der neu gewählte DBMB-Vorstand (v.l.n.r.): Jens Kemmel, Norbert Heyer, Jürgen Richter, Jens Krtschmarsch. Schatzmeister Sjörn Pahl fehlte in der Runde
Foto: Jürgen Richter
Matthias Hajenski, Geschäftsführer der mitgliederstarken Einkaufsorganisation für mittelständische Privatbrauereien, feierte am 1.Oktober 2022 sein 35-jähriges Dienstjubiläum.

(F.) Als er 1987 als Leiter der Geschäftsstelle die Verantwortung in Wetzlar übernahm, zählten 70 mittelständische Privatbrauereien in Deutschland zum
Mitgliederstamm. Heute sind es ca. 220 selbstständige Privatbrauereien aus Deutschland, Österreich und der Schweiz. Im Laufe seiner 35 Dienstjahre hat Hajenski wesentlich zu dieser Entwicklung beigetragen und hat sich sowohl im Mitgliederkreis als auch bei den Partnern der Zulieferindustrie als kompetenter und zuverlässiger Ansprechpartner etabliert.
Der zehntägige Workshop „Craft Brewing in Practice“ konnte nach zwei Jahren Pandemie endlich wieder vor Ort an der VLB durchgeführt werden. Zehn Teilnehmer aus sieben Nationen reisten dafür nach Berlin – die weiteste Anreise hatte ein Teilnehmer aus Japan

IMPRESSUM
Brauerei Forum
Fachzeitschrift für Brauereien, Mälzereien, Getränkeindustrie und deren Partner
Informationsservice der VLB Berlin ISSN 0179–2466
Herausgeber Versuchs- und Lehranstalt für Brauerei in Berlin (VLB) e.V. Seestraße 13, 13353 Berlin
Redaktionsanschrift
Brauerei Forum Seestraße 13, D-13353 Berlin Telefon: (030) 4 50 80-251 Telefax: (030) 4 50 80-210 E-Mail: redaktion@brauerei-forum.de Internet: www.brauerei-forum.de
Redaktion
Olaf Hendel (oh) (verantwortlich) hendel@vlb-berlin.org Eva Wiesgrill (ew), e.wiesgrill@vlb-berlin.org Julia Bork (jb), j.bork@vlb-berlin.org IfGB Aktuell: Wiebke Künnemann (WiK) kuennemann@vlb-berlin.org
Redaktionsbeirat
Dr.-Ing. Josef Fontaine, Dr. sc. techn. Hans-J. Manger
Anzeigenkontakt
VLB PR- und Verlagsabteilung, Tel. (030) 450 80-255 media@brauerei-forum.de Erscheinungsweise
Erscheint mit zehn Ausgaben pro Jahr, zwei davon in Englisch.
Bezugskosten / Abonnement
Abonnement Inland 95 € inkl. MwSt. Ausland 95 € (zuzüglich Porto) Die Mindestvertragslaufzeit beträgt ein Jahr. Danach ist das Abonnement vier Wochen zum Monatsende kündbar. Abonnements Westkreuz Verlag, Berlin Tel. (030) 7 45 20 47 Fax (030) 7 45 30 66 abo@brauerei-forum.de
Druck und Vertrieb Westkreuz-Druckerei Ahrens KG Berlin/Bonn, Töpchiner Weg 198/200, D-12309 Berlin
Alle Rechte vorbehalten. Nachdruck, Ver vielfältigung oder Weiterverarbeitung, auch auszugsweise, ist nur mit ausdrücklicher Genehmigung der Redaktion und Quellenangabe gestattet. Für namentlich gekennzeichnete Beiträge übernehmen Herausgeber und Redaktion keine Haftung.
Hinweis der Redaktion: Um die Lesbarkeit unserer Publikation zu vereinfachen, verzichten wir weitgehend auf die zusätzliche Formulierung der weiblichen Form. Wir weisen aber ausdrücklich darauf hin, dass unsere Verwendung der männlichen Form als geschlechtsneutral zu verstehen ist.
31 Brauerei Forum – Oktober 2022
Brauer-Schule: Lösungen von Seite 16 Fachfragen 1. b) / 2. d) / 3. b) / 4. d) / 5. d) / 6. e) / 7. c) Fachrechnen Volumen des zylindrokonischen Gärtanks bestimmen 5 m Gesamthöhe – 0,8 m Steigraum = 4,2 m nutzbar d² (2 m)2 V Zylinder = ∙ π ∙ h V Zylinder = ∙ 3,14 ∙ 3,0 m = 9,4 m³ 4 4 d² (2 m)2 + VKonus = ∙ π ∙ h + VKonus = ∙ 3,14 ∙ 1,2 m = 1,26 m³ 12 12 Vgesamt Vgesamt 10,7 m³ 107 hl ∙ 0,8 l/hl = 85,6 l = 86 l
Anstellhefe sind erforderlich
Matthias Hajenski führt seit 35 Jahren die Brauring Kooperation
Foto:Brauring
Matthias Hajenski
Foto: ew
Unsere nächste Ausgabe erscheint am 18. November 2022
VERANSTALTUNGEN
VLB-Termine
VLB-Jahrestagung 2022: inkl. Technische Veranstaltung, Braugersten-Seminar, VLB-Forschungskolloquium und Mitgliederversammlung VLB Berlin e.V. 10./11. Oktober 2022, Berlin
Weiterbildung zum/zur Meister/in im Brauer- und Mälzer-Handwerk (HWK) 17. Oktober 2022 bis 27. September 2023, Berlin
Training „Applied Microbiology“ 14. bis 18. November 2022, Berlin
12th VLB Iberoamerican Symposium 21. bis 23. November 2022, Uberlandia, Brasilien
Praxiskurs Mikrobiologie 28. November bis 2. Dezember 2022, Berlin
3rd International Brewing Web Conference (Online) 6./7. Dezember 2022, VLB Virtual Campus
Seminar Brauen für Nichtbrauer 7./8. Dezember 2022, Berlin
24. VLB-Logistikfachkongress 13. bis 15. März 2023, Stralsund
Workshop „Micro Malting in Practice“ 29. März bis 6. April 2023, VLB Berlin
IfGB Destillateur-Meisterkurs 14. August bis 20. Oktober 2023, VLB Berlin
Weitere Termine
DBMB Berlin-Brandenburg, Mitgliederversammlung 25. November 2022, VLB Berlin
Craft Brewers Conference 2023 7. bis 10. Mai 2023, Nashville (TN), USA
Gesellschaft für Geschichte des Brauwesens, Mitgliederversammlung 2023 8. September 2023, VLB Berlin
Brau Beviale 2023 28. bis 30. November 2023, Nürnberg
redaktion@brauerei-forum.de